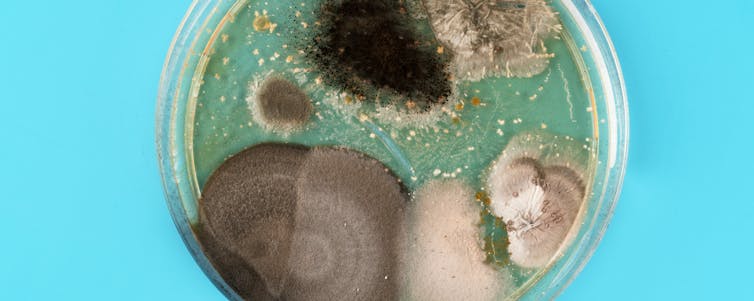

Oxitozina, autismoan ematen den urritasun sozialerako erabilgarria izan daiteke?
Autismoaren espektroaren nahastea jokabidean definitutako garapen neurologikoaren desoreka da. Bi sintoma dira bere bereizgarri nagusi: batetik, urritasun soziala; bestetik, mugimendu errepikakorrak eta murriztaileak. Autismoa garatzen duten haurren ezaugarririk ohikoena urritasun soziala da, eta hau komunikazio berbalean zein ez berbalean ere ikusten da. Izan ere, autismoa duten umeek ez dute seinalatzea gauzatzen nahi duten objektua zein den esateko, eta ez dituzte gauzak ematen ezta erakusten ere ez. Gaixo hauek, sintoma nagusiekin batera, beste sintoma batzuk pairatu ditzakete: atentzio arazoak, ezgaitasun intelektuala, hiperaktibitatea, antsietatea, suminkortasuna, defizit motorea, edo agresibitatea besteak beste.

Nahiz eta autismoaren etiologia eta fisiopatologia oraindik guztiz ezaguna ez izan, badakigu genetikak eragin garrantzitsu bat duela. Autismoak jatorri genetiko konplexua dauka, gaixo gehienek gene bat baino gehiago mutatua baitaukate. Hala ere, autismoa pairatzen duten gaixoek aldaketa genetiko amankomunak dituztela ere zehaztu da, eta hainbat ikerketa egin dira gene hauek identifikatzeko (familietan eta bizkietan egindako ikerketak garrantzitsuak izan dira). Autismoaren klinikaren heterogeneotasunagatik, eta etiologia eta fisiopatologia konplexuagatik, farmakoterapia zuzendu bat garatzea da gaur egungo erronka garrantzitsua. Erabiltzen den ohiko interbentzioa portaeraren terapia bada ere, autismo kasuen %75ak tratamendu farmakologikoa jasotzen du asoziaturiko sintometarako, baina momentuz ez dago sintoma nagusietarako eraginkorrak den farmakorik. Medikamentuen agentzia erregulatzailea den FDAk (Food and Drug Administration) autismorako onartutako medikamentu bakarra antipsikotiko atipikoak dira; hauek suminkortasunean eta agresibitatean daukate eragin terapeutiko nagusia. Beraz, farmako berriak garatzeko ahalegin handia egiten ari da ikerketa biomedikoa, eta hauen artean oxitozina daukagu.
Oxitozina, esne ekoizpenean eta erditze garaiko muskulua uzkurketan parte hartzen duen peptido bat izateaz gain, nerbio sistema zentralean neuromodulatzaile bezala jokatzen du ere. Oxitozina, beraz, hainbat portaera sozialen modulatzailea da, besteak beste, aurpegien ezagutzearen hobetzea, lagun hurkoaren emozioen identifikazioa eta agresioaren murrizketa eragiten duelarik. Gainera, garapen goiztiarrean mutazio genetikoengatik emandako oxitozina-sistemaren porrotak jokaera sozialean eragin dezakela ikusi da, aktibitate eta plastikotasun sinaptikoan eraginez. Testuinguru honetan, oxitozinak autismoaren tratamenduan izan dezakeen erabilgarritasuna eta arrakasta aztertzen ari dira.
Batetik, autismoaren forma monogenikoetan oinarritutako zenbait animalia-ereduk oxitozina sisteman nolabaiteko alterazioak erakusten dituzte, eta hauetan oxitozinaren administrazioak urritasun sozialaren hobekuntza eragiten du. Bestetik, gizakietan ere hainbat saio kliniko burutzen ari dira oxitozinaren erabilgarritasun terapeutikoa aztertzeko. Baina kasu honetan, animalia-ereduetan ikusi denarekin parekatuz, lortutako emaitzak ezberdinak dira, ikerketa batzuetan kognizio sozialean hobekuntzak ikusi direlarik, baina beste batzuetan ez. Gizakien artean dagoen heterogeneotasuna dela eta, hau ez da oso harritzekoa. Ondorioz, ikerketa gehiagoren beharra dago oxitozinak autismoan izan dezakeen erabilgarritasuna modu sendoago batean balioztatzeko eta baita tratamendu mota hau onuragarriena zein banakorentzat izango litzatekeen zehazteko ere. Izan ere, oraindik argitu gabe dago zein den oxitozina emateko biderik egokiena, dosi optimoa, maiztasuna, oxitozinaren eragina epe luzera, eta emakumeetan zein haurretan duen eragina, besteak beste. Erronka handia suposatzen duten ikerketa guzti hauek autismoaren etiologia eta patologiari buruzko mekanismoak hobeto ulertzen lagunduko ligukete, eta gainera, autismoaren sintoma nagusietarako oxitozinaren erabileraren potentzialari buruzko ondorio landuagoak lortuko lirateke.
Iturria:
Ruiz de Mendoza Ruiz de Arechavaleta, Celia; Peñagarikano Ahedo, Olga; Erdozain Fernández, Amaia Maite (2020). «Oxitozina, autismoan ematen den urritasun sozialerako erabilgarria izan daiteke?»; Ekaia, 37, 2020, 241-256. (https://doi.org/10.1387/ekaia.20886) Artikuluaren fitxa:- Aldizkaria: Ekaia
- Zenbakia: Ekaia 37
- Artikuluaren izena: Oxitozina, autismoan ematen den urritasun sozialerako erabilgarria izan daiteke?.
- Laburpena: Autismoaren espektroaren nahastea jokabidean definitutako garapen neurologikoaren desoreka da. Bi sintoma dira haren bereizgarri nagusi: batetik, urritasun soziala; bestetik, mugimendu errepikakor eta murriztaileak. Autismoaren klinikaren heterogeneotasunagatik, eta etiologia eta fisiopatologia konplexuagatik, farmakoterapia zuzendu bat garatzea da gaur egungo erronka garrantzitsua. Erabiltzen den ohiko interbentzioa portaeraren terapia bada ere, autismo kasuen % 75ek tratamendu farmakologikoa jasotzen du asoziaturiko sintometarako, baina momentuz ez dago sintoma nagusietarako eraginkorra den farmakorik. Beraz, farmako berriak garatzeko ahalegin handia egiten ari da ikerketa biomedikoa, eta horien artean oxitozina dugu. oxitozina nerbio sistema zentralean neuromodulatzaile gisa jokatzen duen peptido bat da. Ikusi da garapen goiztiarrean mutazio genetikoengatik gertatutako oxitozina-sistemaren porrotak jokaera sozialean eragin dezakeela eta aktibitate eta plastikotasun sinaptikoan ere bai. testuinguru horretan, oxitozinak autismoaren tratamenduan izan dezakeen erabilgarritasuna eta arrakasta aztertzen ari dira. Batetik, autismoaren forma monogenikoetan oinarritutako zenbait animalia-ereduk oxitozina sisteman nolabaiteko alterazioak erakusten dituzte, eta horietan oxitozina emateak urritasun sozialaren hobekuntza eragiten du. Bestetik, gizakietan ere hainbat saio kliniko egiten ari dira oxitozinaren erabilgarritasun terapeutikoa aztertzeko. Baina kasu horretan, animalia-ereduetan ikusi denarekin konparaturik, lortutako emaitzak ezberdinak dira: ikerketa batzuetan kognizio sozialean hobekuntzak ikusi dira, baina beste batzuetan ez. Gizakien artean dagoen heterogeneotasuna dela eta, ez da oso harritzekoa hori. ondorioz, ikerketa gehiagoren beharra dago oxitozinak autismoan izan dezakeen erabilgarritasuna modu sendoago batean balioztatzeko eta baita tratamendu mota hau zein banakorentzat litzatekeen onuragarriena zehazteko ere.
- Egileak: Celia Ruiz de Mendoza Ruiz de Arechavaleta, Olga Peñagarikano Ahedo, Amaia Maite Erdozain Fernández
- Argitaletxea: UPV/EHUko argitalpen zerbitzua
- ISSN: 0214-9001
- eISSN: 2444-3255
- Orrialdeak: 241-256
- DOI: 10.1387/ekaia.20886
————————————————–
Egileez:
Celia Ruiz de Mendoza Ruiz de Arechavaleta, Olga Peñagarikano Ahedo eta Amaia Maite Erdozain Fernández UPV/EHUko Farmakologia Sailekoak dira.
———————————————–
Ekaia aldizkariarekin lankidetzan egindako atala.
The post Oxitozina, autismoan ematen den urritasun sozialerako erabilgarria izan daiteke? appeared first on Zientzia Kaiera.
Contando lentejas, las particiones de los números
Hace unos años escribí una biografía sobre el matemático británico Arthur Cayley (1821-1895), que es uno de esos matemáticos por los que siento cierta admiración. Arthur Cayley investigó prácticamente en todas las áreas de las matemáticas –escribió 967 artículos y un libro sobre funciones elípticas–, en un tiempo en el que la investigación matemática era como una de esas expediciones geográficas, llenas de aventuras, del siglo XIX y principios del siglo XX, pero por territorio matemático. Escribiendo el libro Cayley, el origen del álgebra moderna aprendí algunas cosas sobre las particiones de los números naturales, tema al que vamos a dedicar esta entrada del Cuaderno de Cultura Científica.

Sin embargo, me gustaría empezar con un poco de literatura. En concreto, con una cita de la novela El contable hindú (Anagrama, 2011), del escritor estadounidense David Leavitt, novela que se centra en la relación de los matemáticos Srinivasa Ramanujan (1887-1920) y Godfrey H. Hardy (1877-1947), y en el ambiente de la Universidad de Cambridge de principios de siglo XX.
Por la mañana, va hasta las habitaciones de Hardy. Cuando se quita el abrigo, las lentejas se le caen del forro.
— ¿Le pasa algo? — pregunta Hardy— Parece agotado.
— Me pasé la noche cocinando. Voy a dar una cena. El martes que viene. Me pregunto si me haría el honor de asistir.
— Pues claro —dice Hardy—. ¿Qué se celebra?
— Que Chatterjee se va a casar. […]
— ¿Está seguro de que se encuentra bien? —pregunta Hardy. Ramanujan asiente con la cabeza.
— Se lo pregunto porque parece un poco distraído. ¿Es por la cena?
— Qué va. Son las lentejas.
— ¿Qué lentejas?
— Las del rasam. —Y Ramanujan se pone a explicarle que, mientras preparaba los ingredientes para el rasam, se dedicó a contar las lentejas, y eso le hizo pensar en las particiones.
No es la primera vez que hablan sobre las particiones. De hecho, tienen la teoría de las particiones en mente (aunque de un modo bastante disperso) desde que Hardy recibió la primera carta de Ramanujan y se topó con un enunciado sobre la serie theta cuya inexactitud permitía enfocar la cuestión desde un ángulo nuevo realmente sorprendente. Calcular p(n) —el número de particiones de un número— es fácil cuando n es 5 o 7; el problema es que, a medida que el número va siendo más alto, p(n) aumenta a un ritmo asombroso. Por ejemplo, el número de particiones de 7 es 15, mientras el número de particiones de 15 es 176. Así que ¿cuál es el número de particiones de 176? 476.715.857.290. Y entonces, ¿cuál sería el número de particiones de 476.715.857.290?
— ¿Y adónde le han llevado las lentejas?
— Tengo una idea sobre una fórmula para calcular el número de particiones de un número. Aunque sea un número muy alto. —Se levanta—. ¿Puedo?
—Claro. —Hardy borra la pizarra, y Ramanujan se acerca a ella. Empieza a trazar diagramas: puntitos que representan las lentejas. Luego escribe la serie theta de su primera carta. Entonces Hardy menciona la función generadora que descubrió Euler, y […].

Pero vayamos con las particiones. Una partición de un número natural es una forma de expresarlo como suma de números naturales, donde el orden no es relevante. Por ejemplo, el número 3 puede expresarse como suma de números naturales de tres formas distintas
1 + 1 + 1, 2 + 1, 3,
es decir, hay tres particiones del número 3, mientras que existen cinco particiones del número 4, a saber,
1 + 1 + 1+ 1, 2 + 1 + 1, 2 + 2, 3 + 1, 4.
Dicho de una forma un poco más técnica, una partición de un número entero positivo n es una sucesión no creciente de números enteros
de forma que su suma es n,
Se denota por p(n) el número de particiones de un número n y por convención se toma p(0) = 1. Calcular las particiones de números pequeños es un problema sencillo, incluso un juego entretenido. Se puede ver fácilmente que p(6) = 11, p(7) = 15, p(8) = 22, p(9) = 30 y p(10) = 42. Sin embargo, la cuestión se complica según vamos avanzando en los números naturales. Por ejemplo, un número bajo como 100 tiene ya p(100) = 190.569.292 particiones, que no es precisamente un número pequeño. Solo en escribir explícitamente las particiones de 100 tardaríamos bastante más de 18 años y eso considerando que se estuviese escribiendo a un ritmo muy rápido y sin parar a descansar en todo el día, las 24 horas del día. O 36 años, a 12 horas diarias. Además, como se menciona en El contable hindú es una función que crece exponencialmente.
Por otra parte, se define como pk(n) el número de particiones del número n con k, o menos, sumandos. Por ejemplo, p3(6) = 7, ya que el 6 se puede expresar como suma de 3, o menos, sumandos de estas siete formas distintas
2 + 2 + 2, 3 + 2 + 1, 3 + 3, 4 + 1 + 1, 4 + 2, 5 + 1, 6.
Mientras que se denota por qk(n) al número de particiones del número n cuyos sumandos son menores, o iguales, a k. Por ejemplo, q3(6) = 7, ya que existen siete particiones del 6 cuyos sumandos son 1, 2 o 3,
1 + 1 + 1 + 1 + 1 + 1, 2 + 1 + 1 + 1 + 1, 2 + 2 + 1 + 1, 2 + 2 + 2, 3 + 1 + 1 + 1, 3 + 2 + 1, 3 + 3.
Se estudian muchos más tipos de particiones: con números impares, con números distintos, con determinado tipo de números, con solo ciertos números, planas, perfectas, etcétera. Además, si en las particiones se tuviera en cuenta el orden se obtendrían las composiciones o particiones ordenadas, pero hoy no vamos a hablar de estas.
La primera referencia a las particiones aparece en una carta, de 1669, del matemático alemán Gottfried Leibniz (1646-1716) al matemático suizo Johann Bernoulli (1667-1748), aunque las llama «divulsiones». Sin embargo, fue Leonhard Euler quien realizó el primer estudio serio de las particiones en su libro Introductio in analysin infinitorum (1748). Además de Euler, han estudiado las particiones de los números matemáticos como Arthur Cayley, James J. Sylvester (1814-1897), Percy A. MacMahon (1854-1929), Godfrey H. Hardy, Srinivasa Ramanujan y muchos más.

En el texto Introductio in analysin infinitorum, Leonhard Euler expresó la sucesión de los números de particiones {p(n)} como coeficientes de una función generatriz, una serie infinita de potencias. En concreto, demostró que
pero no vamos a explicar en esta entrada del Cuaderno de Cultura Científica el significado e importancia de esta potente fórmula matemática, sino que vamos a mostrar una técnica más visual de estudio de las particiones de los números, los denominados diagramas de Ferrers.
Norman Macleod Ferrers (1829-1903) fue un matemático británico de la Universidad de Cambridge, como muchos de los protagonistas del estudio de las particiones de los números. Un diagrama de Ferrers es un diagrama de puntos en el que cada partición se representa con una serie de puntos de forma que en cada fila haya tantos puntos como el número que se está sumando. Por ejemplo, la partición 21 = 6 + 4 + 4 + 2 + 2 + 2 + 1 se representa con una fila de seis puntos, dos de cuatro puntos, tres de dos puntos y una de un punto, como se ve en la siguiente imagen.
Si en el diagrama de Ferrers de una cierta partición se intercambian las filas por las columnas, se obtiene el diagrama de una nueva partición del mismo número, que es la denominada partición conjugada de la primera. Por ejemplo, si al diagrama de la imagen anterior, correspondiente a la partición 21 = 6 + 4 + 4 + 2 + 2 + 2 + 1, se le intercambian filas y columnas, se obtiene el diagrama de la partición conjugada de la anterior, la partición 21 = 7 + 6 + 3 + 3 + 1 + 1.
Observando los diagramas de Ferrers de particiones conjugadas se deduce que dada una partición de un número n con k, o menos, sumandos (el número de sumandos se corresponde con el número de filas, que no puede ser mayor que k), su partición conjugada es una partición de n donde los sumandos son números menores, o iguales, que k (puesto que ahora el número de puntos de cada columna no puede exceder k, que era la cantidad de filas que había antes). Y el recíproco también es cierto. Por ejemplo, en las imágenes anteriores, la partición 6 + 4 + 4 + 2 + 2 + 2 + 1, tiene siete o menos sumandos, y su conjugada, 7 + 6 + 3 + 3 + 1 + 1, tiene sumandos que no son mayores que siete.
En consecuencia, los diagramas de Ferrers ofrecen una sencilla demostración de la «bella ley de Euler», como la denominó Sylvester,
pk(n) = qk(n),
es decir, el número de particiones de n con k, o menos, sumandos es igual al número de particiones con sumandos que no exceden a k.
Veamos otro resultado sencillo que puede demostrarse con la ayuda de estos diagramas:
pk(n) = pk – 1(n) + pk(n – k).
Como ya hemos mencionado en más de una ocasión en la sección Matemoción del Cuaderno de Cultura Científica las demostraciones son una parte muy importante, de hecho, fundamental, de las matemáticas, por lo que este ejemplo nos sirve para ilustrar el proceso de una demostración matemática.
Vamos a demostrar la anterior fórmula. Es decir, la vamos a demostrar que pk(n) –el número de particiones del número n con k, o menos, sumandos- es igual a la suma de pk – 1(n) –el número de particiones del número n con k – 1, o menos, sumandos- y pk(n – k) –el número de particiones del número n – k con k, o menos, sumandos-. Para demostrarlo vamos primero a dividir el conjunto S de particiones del número n con k, o menos, sumandos en dos subconjuntos, a saber, el subconjunto S1 de particiones del número n con exactamente k sumandos y el conjunto S2 de particiones del número n con menos de k sumandos. Luego si contamos la cantidad de elementos de los subconjuntos S1 y S2, obtendremos que su suma es igual al número de elementos del conjunto S, esto es, pk(n).
Pero claramente el conjunto S2 es igual al conjunto de particiones del número n – 1 con k, o menos, sumandos, de donde se deduce que la cantidad de elementos de S2 es igual a pk – 1(n).
Para obtener el número de elementos de S1 vamos a utilizar los diagramas de Ferrers. Como los elementos de S1 tienen exactamente k sumandos, sus diagramas de Ferrers tienen exactamente k filas, como se muestra en el ejemplo de la imagen, luego si se elimina la primera columna –que para cualquier elemento de S1 tiene k puntos- se obtiene una partición de n – k (ya que se han quitado k puntos) con k, o menos, sumandos. Por lo tanto, el número de elementos de S1 es pk(n – k).

En conclusión, pk(n) es igual a la suma de las cantidades de elementos de S1 y S2, luego pk(n) = pk – 1(n) + pk(n – k); QED (Quod erat demonstrandum).
Otra propiedad, esta vez de las particiones autoconjugadas –aquellas particiones de un número que son iguales a sus conjugadas-, que se puede probar fácilmente de forma visual teniendo en cuenta los diagramas de Ferrers es la siguiente:
El número de particiones autoconjugadas es igual al número de particiones con números impares distintos.
La idea que subyace a esta prueba es que una línea con un número impar de puntos se puede plegar en una partición autoconjugada (con una única fila y una única columna, con la misma cantidad de puntos en ambas), como en la siguiente imagen.
A partir de la anterior idea se puede observar que el número de particiones autoconjugadas es igual al número de particiones con números impares distintos, sin más que aplicar el plegado a cada una de las filas con un número impar de puntos, todos ellos distintos, como se muestra en la siguiente imagen.
Observemos que si hay dos columnas con el mismo número impar de puntos no se genera una partición autoconjugada, como se muestra en el siguiente ejemplo.
Estos ejemplos nos sirven para mostrar, una vez más, como en ocasiones podemos diseñar herramientas visuales potentes para realizar demostraciones matemáticas, como son el caso de los diagramas de Ferrers en el estudio de las particiones de los números.

Aunque pueda sorprender por su sencillez, las particiones de los números, como muchas otras herramientas de la combinatoria, tienen muchas aplicaciones en ciencia y tecnología. Aparecen en ocasiones en las que hay que contar determinado tipo de elementos o estructuras que pueden pensarse como particiones de los números. Por ejemplo, el matemático inglés Arthur Cayley se interesó en el estudio de la teoría de particiones como herramienta en el cálculo de ciertos invariantes algebraicos, pero lo mismo ocurre con muchas otras ramas de las matemáticas, y también de la física de partículas, la computación o la estadística, entre otras.
Más aún, las particiones están relacionadas, por ejemplo, con lo que en teoría combinatoria se llaman “problemas de ocupación”, que consisten en contar el número de formas de colocar una cierta cantidad de bolas n en una cierta cantidad de cajas k. Las particiones, en general, se corresponden con los problemas en los que las bolas son indistinguibles. Si las cajas son también indistinguibles, son las particiones propiamente dichas, y si son distinguibles, son las particiones ordenadas. Un ejemplo, de una aplicación de un problema de ocupación lo mostramos en la entrada Aprendiendo técnicas para contar: lotería primitiva y bombones.
Bibliografía
1.- Raúl Ibáñez, Cayley, el origen del álgebra moderna, Genios de las Matemáticas, RBA, 2017.
2.- R. B. J. T. Allenby, Alan Slomson, How to count, an introduction to combinatorics, CRC Press, 2011.
Sobre el autor: Raúl Ibáñez es profesor del Departamento de Matemáticas de la UPV/EHU y colaborador de la Cátedra de Cultura Científica
El artículo Contando lentejas, las particiones de los números se ha escrito en Cuaderno de Cultura Científica.
Entradas relacionadas:Mahastien modernizazioak ondorioak ditu hegaztiek eta ugaztunek mahastiak erabiltzeko moduan
UPV/EHUko Zoologia eta Animalien Biologia Zelularreko Saileko lan batek, IRECeko eta Michigan Estatuko Unibertsitateko ikertzaileekin batera, mahastietan bizi ohi diren hegaztietan eta ugaztunetan mahastien modernizazioak duen eragina aztertu du, eta egiaztatu du espezie desberdinak daudela mahasti tradizionaletan eta besorakoetan, eta espeziearen araberakoa dela mahasti mota bat edo beste bat aukeratzearen aldeko apustua.
Mendeetan zehar, mahastiak asko landu dira Mediterraneoko eskualdean. Gaur egun, mahasti-azalera handia du Espainiak eta berregituratze- eta areagotze-prozesu sakona jasaten ari da, besorako mahastiak ezarriz. Prozesu hori Europar Batasuna sustatzen ari da kostuak murrizteko eta produktibitatea handitzeko. Mahasti tradizionalak besorako mahasti bilakatzeak mahats altuagoak eskatzen ditu, bilketa mekanizaturako mahatsondo-ilara arteko distantzia handiagoa, ureztatzeko sistema eta lur-zati handiagoak.

“Mahastiak modernizatzeak dituen ondorioak oso ezezagunak dira oraindik, eta mahastiaren berregituraketak eragina izan dezake haietan bizi den faunan. Beraz, funtsezkoa da ulertzea nekazaritzaren modernizazioak nola eragiten dion biodibertsitateari. Lan honen helburua hau da: mahastiaren egitura eta erabilera zertan aldatzen den ikustea eta nekazaritza-ingurune horietan normalean bizi diren hegazti eta ugaztunetan zer eragin duen kalkulatzea”, adierazi du Xabier Cabodevilla Bravok, UPV/EHUko Zoologia eta Animalien Biologia Zelularreko Departamentuko ikertzaileak. Horretarako, Espainiako hego-mendebaldeko 52 mahasti (26 tradizionalak eta 26 besorakoak) aztertu dituzte udan, mahastiaren egitura eta mahastietan egindako kudeaketa-praktikak konparatuz, eta mahasti-mota bakoitzean ohikoenak diren hegazti eta ugaztunak behatu dituzte.
Cabodevillaren arabera, “mahastien modernizazioak ondorio nabarmenak ditu faunaren biodibertsitatean, baina ez du eragin negatibo orokorrik hegaztiek eta ugaztunek mahastiari egiten dioten erabileran. Ikusi dugu espeziearen araberakoa dela eta espezie batzuk (eper gorria, buztantentea, kardamirua, txolarrea eta zozoa) besorako mahastietan ageri dira sarri eta beste batzuk (txorrua eta untxia), berriz, mahasti tradizionaletan. Hala ere, gauza jakina da ikerketa honetan aztertu ez diren beste zenbait espezie babesturentzat, hala nola, basoiloa, besorako mahastiak kaltegarriak direla”.
Ikerketan ere ikusi dute espezie batzuek mahastiak erabiltzen dituztela mahastiaren ondoko lurrak goldagarriak badira. Adibidez, eper gorria eta Europako untxia agertzeko probabilitatea handiagoa da mahastiak lur goldagarrien ondoan daudenean. Horrek iradokitzen du mahastiak ez direla espezie horientzako habitat egokienak. Izan ere, espezie horiek, seguruenik, mahastiak erabiltzen dituzte udan babesleku gisa, zereala uzta eginda dagoenean, bere egituragatik eta eguneko ordu beroenetan berotik babesteko itzal-eskaintzagatik.
Mahasti tradizionalen eta besorako mahastien arteko kudeaketaren beste desberdintasun nagusietako bat ureztaketa da. “Baliabide hidriko hori erakargarria izan liteke, halaber, hegazti edo ugaztun askorentzat udan. Gainera, ureztatze-sistemak ongarriak gehitzeko aukera ematen du, batez ere nitratoak. Hori arrisku larria izan daiteke ur hori edaten duten animalientzat. Jarduera hori, udan, besorako mahastien heren batean aplikatzen da ur-iturri naturalak urriak direnean, eta bereziki arriskutsua izan daiteke baliabide hidriko toxiko horrek erakarrita gerturatzen den faunarentako”, adierazi duUPV/ EHUko ikertzaileak.
Ikertzaileek aurreikusita dute aztertzen jarraitzea ureztapenak zer neurritaraino erakartzen dituen lehorreko laborantzako lurretako hegaztiak eta bestelako animalia basatiak besorako mahastietara, eta zenbatestea ureztatze-sistemaren bidez ura eta ongarriak aldi berean aplikatzean zenbatekoa den nitrato dosi toxikoen eraginpean egoteko arriskua.
Iturria:UPV/EHU prentsa bulegoa: Mahastien modernizazioak ondorioak ditu hegaztiek eta ugaztunek mahastiak erabiltzeko moduan
Erreferentzia bibliografikoa:Cabodevilla, Xabier; Arroyo, Beatriz; Wright, Alexander D.; Salguero, Antonio J.; Mougeot, Francois (2021). «Vineyard modernization drives changes in bird and mammal occurrence in vineyard plots in dry farmland»; Agriculture, Ecosystems and Environment (DOI: 10.1016/j.agee.2021.107448)
The post Mahastien modernizazioak ondorioak ditu hegaztiek eta ugaztunek mahastiak erabiltzeko moduan appeared first on Zientzia Kaiera.
Montañas y explicaciones naturalistas
Incluso cuando las sociedades mediterráneas se volvieron más sofisticadas y la mente científica griega despertó del letargo, las montañas seguían siendo distantes, misteriosamente temibles e inaccesibles. Era tal el efecto que producían a quien se aventuraba en ellas que, como a Polibio, que viajó a través de los Alpes y vio el monte Atlas a la distancia, solo las cifras equivalentes al infinito servían para describirlas.

Los pocos ascensos de montañas registrados se produjeron por razones militares. Así, Alejandro de Macedonia en el siglo IV a.e.c. cruzó las montañas Tauro del sureste de Turquía y el Hindú Kush de Afganistán. Aníbal de Cartago atacó Roma en el 218 a.e.c. después de haber cruzado los Pirineos y luego los Alpes. El historiador romano Livio registró el ascenso del monte Hebrus en Tracia a principios del siglo II a.e.c. por parte del rey Filipo de Macedonia, en guerra con Roma. Filipo habría subido a la montaña para espiar los movimientos de las tropas romanas. Los montañeros tardaron tres días en atravesar las estribaciones y ascender a la cima. El descenso posterior duró dos días. El sufrimiento de los hombres fue inmenso, sobre todo por el frío; la tercera noche en la cumbre fue terrible en este sentido. Según Livio, quien obviamente sabía poco sobre montañismo, la espesa niebla que envolvió a Filipo y sus hombres en la cima era un fenómeno inusual.
Los griegos, y después de ellos los romanos, rara vez intentaron explicar los fenómenos montañosos. La ciencia requiere no solo observación, sino análisis basado en la experiencia directa y, cuando es posible, en la experimentación. Y a los griegos les faltó la voluntad de ascender a las altas cumbres. Además, las montañas se consideraban sagradas, asociadas con lo sobrenatural y trascendente.
Lucrecio el epicúreo, que se negaba a creer en todo lo que no pudiera explicarse según la materia en movimiento, el movimiento perpetuo de los átomos invisibles [1], no hizo una excepción con las montañas y los fenómenos asociados a ellas. Las montañas son huecas, creía Lucrecio, y las erupciones volcánicas ocurren cuando los átomos de fuego son expulsados del cono. Más cercana a la realidad fue su observación de que las nubes se forman en los picos de las montañas debido al aire caliente que sube por las laderas hacia el frío de la cumbre.

El romano más famoso que investigó las montañas fue Cayo Plinio Secundo, Plinio el Viejo. En el 79 e.c. el Monte Vesubio entró en erupción, arrojando cenizas, gases y lava. Plinio, que podía ver el volcán desde su casa en la bahía de Nápoles, se hizo a la mar para investigar la densa columna de humo que se elevaba desde el Vesubio. Tomó notas de sus observaciones y cuando el barco llegó a las costas al sur de Pompeya, continuó observando la caída de ceniza y rocas hasta su muerte por asfixia [2].
Contemporáneamente, en el siglo I e.c., una nueva secta palestina, los cristianos, supusieron una renovación de la fascinación judía con las montañas. Su líder fundador, Jesús de Nazaret, encontró, como Moisés milenios antes en el Sinaí o Zacarías en el Monte de los Olivos, significado y trascendencia en las pequeñas montañas que rodean Jerusalén. Sin embargo un teórico de la ya religión, Agustín de Hipona, varios siglos después, condenó la fascinación humana por las montañas a expensas de la autoconciencia. La influencia de san Agustín explica el desdén de la europea medieval hacia los monumentos físicos al Creador y su concentración en lo incorpóreo y espiritual. Hubo que esperar al Renacimiento para que se despertase de nuevo el interés por las montañas, y fue con una excusa espiritual: el humanista y montañista Francesco Petrarca en el siglo XIV mostró las posibilidades de autodescubrimiento y contemplación en la experiencia de ascender una montaña.

Nota:
[1] Algunos periodistas televisivos, al informar sobre erupciones volcánicas, siguen a Lucrecio, sin saberlo. Es más, oyéndoles uno pensaría que creen que la lava es algo que está ardiendo, pero uno no lo piensa porque no puede creer que la ignorancia y la incompetencia lleguen a esos niveles.
[2] En vulcanología se llama erupción pliniana a la erupción violenta de un volcán liberando gases en una columna eruptiva que puede alcanzar decenas de kilómetros, como la del Vesubio, en honor a Plinio el Viejo.
Sobre el autor: César Tomé López es divulgador científico y editor de Mapping Ignorance
El artículo Montañas y explicaciones naturalistas se ha escrito en Cuaderno de Cultura Científica.
Entradas relacionadas:- Montañas y mitos
- En Marte el viento crea montañas
- Galileo vs. Iglesia Católica redux (III): Observaciones
Tokian tokiko jarduera: simulazio hiperrealistak
Etorkizun distopiko batean, gizateria, jakin gabe, preso dago errealitate simulatu batean, Matrix batean. Errealitate hori makina adimendunek sortu dute, gizakia ohartu gabe egon dadin, haien gorputzak energia iturri modura erabiltzen duten bitartean. Horixe zen Matrix filmaren oinarria, 1999an wachowskitarrek sortu zuten lana. Ikuspegi termodinamikotik argumentua oso efizientea ez bada ere, bere inpaktu kulturala nabarmena da, eta filmaren izenburua kaleko hizkeran erabiltzen da asmatutako eta errealitatetik banandutako mundu batean bizi garela adierazteko.
Hala ere, simulazio batean bizi garen ideia ez da berria inolaz ere. Historian konstante bat da, adibidez, hinduismoko munduaren ilusioa (maia), Zhuang Zhouk tximeleta taoista bat zela amestu zuen unea, Platonen kobazuloa, Descartesen jeinu gaiztoa (malin génie), Berkeleyren Jainkoa, kubetan dagoen saguzarra, eszeptikoaren tentaldi solipsista, alegia, existitzen den gauza bakarra nire kontzientzia eta informazioa ematen dion zerbait dela dioen ideia.

Gure unibertso guztia zibilizazio hiperaurreratu bateko ordenagailu simulazio bat besterik ez den ideia ezin da hala-hola baztertu. Soilik Ockhamen labana aplikatuz esan genezake ez dirudiela oso gertagarria. Hala ere, 2003an Nick Bostrom-ek 2003an Philosophical Quarterly aldizkarian artikulu bat argitaratu zuen, “Ordenagailu bateko simulazioan bizi zara?” izenburuarekin, eta horrekin “simulismo” deritzon mugimendu metafisiko bat sortu zen –ez epistemologikoa– errealitatea simulazio bat dela dioena.
Bitxiki, gizakiok ezagutzen ditugun gauzekin konparatzen ditugu beste gauza batzuk. Gure ezagutzak denborarekin aurrera egiten duen moduan, konparazioek ere haiekin batera egiten dute aurrera. Adibide ohikoena garunaren funtzionamendua da; izan ere, garunaren funtzionamendua unean uneko teknologia aurreratuen eta harrigarrienarekin alderatzen da, eta misterioarekin lotu. Hala, Descartesek entzefaloa makina hidrauliko batekin konparatu zuen; Freudek, bapore makina batekin; gerora, telefonogune batekin konparatu zen eta, azkenik, ordenagailuarekin; azkenaldian batzuek garuna web nabigatzaile batekin edo Internetekin konparatzen dute.
Etorkizuna imajinatzen dugunean joera kognitibo horren beraren preso gaude. Unibertsoa simulazio bat izan daitekeela uste dutenen oinarria errealitate birtualak gaur egun egin dezakeena da, eta horrek baliozkotasun emozionala ematen dio konparaketari, baina, horrek ez du esan nahi probabilitate handiagoa duenik egia izateko.
Izan ere, errealitate birtuala geroz eta leku gehiagotan dago, garuneko infartua izan dutenen errehabilitazio guneetan, bideo jokoetan (mota guztietakoak) eta oso zeregin konplexuak eta arriskutsuak egiten dituzten langile adituak modu seguruan entrenatzeko simulazio hiperrealistetan ere bai.
Virtualware euskal enpresak ongi irudikatzen du errealitate birtualarekin zer lor daitekeen; adibidez, GE Hitachi Nuclear Energyrentzat simulazio bat sortu dute eta, bertan, zentral nuklear bateko erregai erradioaktiboaren mugimenduaren entrenamendu errealista egin daiteke. Zeregin horretan, ezagutzak eta langileen arteko koordinazioa maila gorenekoak dira, eta errealitatearekin bat ez datorren edozerk ondorio larriak izan ditzake.
Egileaz:Cesár Tomé López (@EDocet) zientzia dibulgatzailea da eta Mapping Ignorance eta Cuaderno de Cultura Cientifica blogen editorea.
Itzulpena: UPV/EHUko Euskara Zerbitzua.
The post Tokian tokiko jarduera: simulazio hiperrealistak appeared first on Zientzia Kaiera.
Julio Garavito, con la mirada en la Luna
Alberto Mercado Saucedo
El billete de veinte mil pesos colombianos es un raro ejemplo: lleva impreso el retrato de un matemático. En efecto, entre sus similares de los países de habla hispana es común encontrar militares y políticos, algunas personalidades de la pintura o de la literatura, pero casi nunca de las ciencias. Este billete lleva impresas figuras geométricas, una representación de la Luna y la imagen de Julio Garavito Armero. Su uso en las transacciones cotidianas ha llevado a una curiosa costumbre urbana alrededor de la tumba de Garavito en el cementerio de Bogotá, que se ha convertido en objetivo de visitas espontáneas de diversas personas, especialmente en medio de la noche, que dejan pequeños regalos como flores azules, del mismo color del billete, en solicitud o agradecimiento de favores personales. Como si fuera un santo a quien acuden en peregrinación. Su nombre también aparece en otro inusual lugar: un cráter de la Luna. Julio Garavito Armero, esta es su historia.
Nació en Bogotá el 5 de enero de 1865. De joven, al tiempo que asistía a la escuela, trabajó para contribuir al ingreso de la familia y después de sus estudios secundarios se interesó por seguir aprendiendo ciencias. Como frecuentemente ocurría durante el siglo XIX (y parte del XX) en países de Latinoamérica, la enseñanza de las matemáticas estaba mayormente enfocada a la ingeniería, área que estudiaban quienes se sentían atraídos por la disciplina de Pitágoras. Además, los distintos cambios políticos de la época, usualmente violentos, afectaron el desarrollo de las ciencias, como ocurrió con los planes de Garavito: a causa de la guerra civil colombiana de 1885, la Universidad Nacional cerró por algún tiempo y él debió esperar a que reabriera para poder estudiar.
Finalmente estudió en la Facultad de Matemáticas e Ingeniería, donde además de los estudios de ingeniería, se podía optar al titulo de profesor de matemáticas, para lo cual se debía de realizar una tesis de temática adecuada. Garavito fue el primer graduado como profesor de matemáticas. Podemos encontrar registros de dos trabajos de tesis que realizó: uno donde estudia matemáticamente el funcionamiento de un barómetro, aparato para medir la presión de un gas, y una segunda tesis donde estudió el problema que hoy conocemos como la aguja de Buffon, que consiste en calcular la probabilidad de que una aguja, arrojada a una superficie reglada por líneas paralelas (como una hoja de cuaderno) separadas por la misma longitud de la aguja, resulte en una posición en que toca a una de las líneas. La solución no se obtiene directamente por algún proceso de conteo y son necesarios argumentos de geometría integral para obtener el resultado: el valor de 2/. De manera interesante, esto proporciona un método práctico para aproximar a (se debe realizar el experimento repetidas veces, digamos N, contar el número de casos favorables A, y entonces A/N se acercará a 2/ cuando N es grande, de donde se puede despejar el valor de ).
Después de graduarse, Garavito dictó clases en la Facultad y se fue interesando cada vez más en lo que se convertiría en su pasión por el resto de su vida: la Astronomía. Ideó métodos para establecer latitudes y longitudes del país, llevó a cabo con éxito un proyecto para cartografiar Colombia y en particular para obtener la latitud de Bogotá. También trabajó en la predicción del paso del cometa Halley. Fue director del Observatorio Nacional desde 1892 y hasta su muerte, ocurrida el 11 de marzo de 1920, cuando tenía apenas 55 años de vida.
Quizá el más grande logro científico de Garavito es el relacionado con sus cálculos sobre el movimiento lunar, lo que está incluido en varios de sus trabajos, en particular en uno de sus artículos de la Academia Colombiana de Ciencias. Extendiendo un método propuesto anteriormente, resolvió las ecuaciones que rigen el movimiento de la Luna alrededor de la Tierra. La teoría de la gravitación universal, desarrollada con Newton un par de siglos antes, junto con todas las herramientas del cálculo diferencial, habían proporcionado un marco matemático para modelar, de manera precisa, el movimiento de los astros. Pero la Luna ha tenido por costumbre volver locas a las personas, y ésta no fue una excepción. Siendo el cuerpo celeste más cercano a nosotros, se le ha observado desde la antigüedad, y la comparación con las observaciones se convirtió en una verdadera prueba para la teoría de gravitación, que no era evidente que aprobara fácilmente.
La ley de gravitación universal permitió comprender de forma conjunta dos fenómenos que ya se habían estudiado: la ley de inercia y las leyes de Kepler del movimiento elíptico. Con las nuevas herramientas matemáticas comenzó una era en la que los detalles del universo podrían cabalmente ser descritos. La luz de las matemáticas iluminó rincones que habían permanecido oscuros. Nació así el área de estudio con el bello nombre de mecánica celeste. En particular, surgió un problema que en términos generales se puede plantear de la siguiente manera: si se conocen las posiciones y velocidades iniciales de N cuerpos celestes en el espacio, los cuales afectan unos a otros por medio de la gravedad ejercida mutuamente, se debe determinar las posiciones y velocidades que tendrían en el curso del tiempo. Para N=2, se tiene un sistema de dos cuerpos, (pensemos en el Sol y la Tierra), que fue resuelto poco después de que Newton estableciera su teoría. Pero para valores mayores, la cuestión es mucho más compleja.
Es asombroso pensar que, en el problema de los N cuerpos, aumentar un objeto para simplemente pasar de dos a tres cuerpos (el Sol y dos planetas girando a su alrededor, por ejemplo) complica enormemente la complejidad del problema, y ya no hay soluciones explícitas. A finales del siglo XIX, el matemático francés Poincaré encontró que este tipo de sistemas siempre incluyen soluciones caóticas (esto significa que pequeños cambios en la situación inicial de los cuerpos pueden llevar, con el curso del tiempo, a inmensas diferencias). Actualmente se conocen algunas soluciones particulares, en particular para el caso de tres cuerpos de la misma masa, pero no del problema en general. Es interesante constatar que recién el año 2000 fue encontrada un nuevo tipo de órbitas de tres cuerpos: la figura del ocho, que es recorrida por tres planetas distribuidos de forma simétrica a lo largo de la trayectoria y que se persiguen mutuamente. Esto fue encontrado por el matemático estadounidense Richard Montgomery en lo que significó un importante descubrimiento. Como dato curioso, la conocida novela de ciencia ficción El problema de los tres cuerpos, de Cixin Liu, se inspira en la trayectoria encontrada por Montgomery.

Dentro del problema de los tres cuerpos, es natural pensar en el ejemplo de los tres astros que tenemos más cerca en nuestra vida diaria: nuestro hogar la Tierra, el Sol y, claro, la Luna. Este sistema tiene la peculiaridad de que un cuerpo es de masa mucho menor comparada con los otros dos, por lo que podemos pensar en una simplificación: considerarlo como un punto en el espacio, con masa despreciable. Además, se puede simplificar pensando que los tres cuerpos se mueven dentro de un plano. Entonces resulta lo que se conoce como el problema restringido de los tres cuerpos, planteado por Poincaré y que ha sido estudiado a lo largo del tiempo.
Uno de los principales aportes en el problema restringido de los tres cuerpos fue realizado por George William Hill (1838-1914) y continuado por Ernest William Brown (1866-1938). La teoría de Hill-Brown, construida a finales del siglo XIX, fue un gran avance en el estudio del movimiento lunar y sirvió como el método más preciso para calcular las efemérides lunares por décadas. Uno de los puntos geniales en este trabajo fue el uso de series complejas infinitas por Hill, quien usó su conocimiento fino de la teoría desarrollada por Euler sobre números complejos (recordemos la fórmula de Euler, la más hermosa de las matemáticas: exp( i) = -1), para encontrar una solución periódica al problema restringido de los tres cuerpos. Fue tal el éxito de esta teoría que astrónomos proponían medir el tiempo usando las efemérides lunares en vez del tiempo universal (lo cual no tuvo mayor éxito, en parte por el descubrimiento de precisos métodos de cálculo del tiempo usando relojes atómicos).
Pues bien, aún siendo muy precisa, la teoría de Hill-Brown no bastaba para describir completamente el movimiento lunar en todos sus detalles, y con el tiempo aparecieron más y más discrepancias entre las observaciones y la teoría. Garavito se abocó a la tarea de mejorar tal teoría, lo que consiguió después de mucho trabajo. Mejoró los resultados de Hill y Brown, resolviendo las ecuaciones diferenciales de la teoría con varios grados mayores de precisión. Llegó a construir las tablas del movimiento lunar más adelantadas de su época. En 1970, la Unión Astronómica Internacional decidió asignar el nombre de Garavito a un cráter de la Luna, en conmemoración de este inmenso logro intelectual. En la Luna, Garavito es vecino de Poincaré y otros nombres de científicos que también fueron asignados a varios cráteres.
Garavito también se interesó en problemas de álgebra y geometría. Por ejemplo, publicó una demostración original del Teorema Fundamental del Álgebra y de varias propiedades de geometría no euclidiana, entre las cuales está una demostración … del Quinto Postulado de Euclides. Evidentemente, una demostración equivocada, pues sabemos que tal axioma es independiente de los otros, aunque muchas personas se empeñaron en demostrar lo contrario a lo largo de la historia. Y sucede que Garavito tuvo una relación complicada con las geometrías no euclidianas, la que podríamos resumir diciendo que simplemente no las aceptaba, no le hacían sentido como modelo de la geometría del universo real. Comprendía bien y dominaba los resultados referentes a propiedades geométricas de la esfera y de las geometrías hiperbólicas (de hecho, publicó varios artículos en tales temas, más allá de sus intentos por probar el Quinto Postulado). Pero todo parece indicar que, para Garavito, la euclidiana era la geometría del universo.
¿Qué es la geometría no euclidiana? Como su nombre lo indica, es la teoría que se sigue cuando nos salimos de las reglas establecidas por Euclides, el conocido geómetra de la Grecia clásica. No se trata de que Euclides se haya equivocado o que queramos corregirlo. Euclides realizó un compendio de lo que se sabía de Geometría, con la característica que lo escribió como un sistema lógico completo: primero los axiomas, que son algo así como las reglas básicas del juego, establecidas como verdades absolutas, de los cuales se desprenden los teoremas, las propiedades de las figuras y toda la teoría. Uno de esos axiomas causaba especial atención: el Quinto Postulado, que afirma que siempre es posible trazar paralelas a una recta dada, exactamente una paralela para cada punto exterior a la recta. Sucede que algunas personas creían que tal propiedad se podría deducir de los demás axiomas, quizá por considerarla tan natural y evidente. Eso habría vuelto el Quinto Postulado como innecesario, se habría convertido en un teorema. Podemos pensar que Euclides tuvo bastante intuición al incluirlo como postulado, sobre todo por todo lo que ocurrió durante los siglos siguientes.
Con el tiempo, ocurrieron muchos intentos por demostrar el Quinto Postulado, aparecían artículos donde se afirmaba que se tenía una prueba matemática, que con el tiempo era descubierto que tenía un error. Se dice fácil, pero es impresionante darse cuenta de que pasaron unos 18 siglos para que a alguien se le ocurriera una jugada genial: no intentar demostrar el axioma, sino negarlo. Es decir, considerar el juego que se obtiene al cambiar esta regla: al fin y al cabo, si éste no es un resultado que depende de los demás axiomas, entonces puede considerarse independiente, y por tanto su negación proporcionará otro sistema lógico con validez. Eso fue lo logrado por Bolyai, Lobachevsky y otros matemáticos del siglo XIX. Fue una jugada genial, pues surgieron teorías matemáticas precisas e interesantes. Básicamente hay dos opciones cuando se niega el Quinto Postulado: que no existe ninguna paralela o que exista más de una. En la segunda opción nos encontramos con lo que se conoce como geometría esférica: los meridianos en la tierra son las rectas, pues realizan la distancia más corta entre dos puntos (es decir, un círculo máximo es la trayectoria que realiza la trayectoria de un avión). Pues bien, dos meridianos siempre se intersectan (en dos puntos opuestos) y por tanto, en la geometría esférica no hay paralelas. Por otra parte, si asumimos que hay más de una paralela, se llega a lo que se conoce como geometría hiperbólica, la que, para sorpresa (y rechazo) de muchas personas de ciencia, llegaría a mostrarse como un modelo del universo.
Regresando a Garavito, todo indica que comprendía las geometrías no euclidianas, pero no las consideraba sino meros malabarismos de las matemáticas puras (citando a Alvárez Lleras, su principal biógrafo). Artificios alejados de la sólida estructura edificada por Euclides y en la cual se basa la física de Newton y de Laplace, la verdad absoluta e inmutable del universo real que habitamos. Hay evidencia que indica que esta postura pudo haber sido motivada por la fuerte influencia del positivismo en el espacio y tiempo que habitaba Garavito. Lo que está claro es que, ya para entonces, se conocían contradicciones entre observaciones astronómicas y la teoría clásica, como el célebre experimento de Michelson y Morley, que hoy sabemos es explicado por la teoría de la relatividad, que justamente establece que el espacio-tiempo de nuestro universo se comprende nítidamente a través de los lentes de la geometría no-euclidiana, pues la gravedad ocasiona una curvatura que los dominios de Euclides simplemente no permiten. Pero, para muchas personas, no era claro si tales discrepancias se debían a errores de cálculo o a algo más profundo.
En su momento, la teoría de la relatividad tuvo oposición en el medio científico. No es difícil imaginarlo, dado el cambio de paradigma que traía consigo. Probablemente Garavito, como muchos otros, consideraba la teoría desarrollada por Newton como la culminación del poder de las matemáticas para modelar el universo: Como ya mencionamos, por medio de la teoría de la gravitación y usando el cálculo infinitesimal es posible calcular el movimiento de los cuerpos celestes. Las discrepancias con lo observado eran producto de los factores no tenidos en cuenta o de las aproximaciones particulares usadas en cada cálculo. Todo era cuestión de mejorar los métodos, alcanzar mejores aproximaciones, como él mismo hizo respecto a los cálculos de Brown-Hill, y listo. No había más que matematizar los fenómenos por estudiar. Como ya lo dijimos, es la influencia del positivismo, corriente filosófica que otorga completa confianza en los fenómenos observados, los cuales tienen un carácter positivo, y elimina posibles explicaciones alternativas. Se tiende siempre a la búsqueda de leyes universales que funcionen en todo contexto, y los detalles son menospreciados. Para Garavito, las discrepancias en las observaciones astronómicas eran de una naturaleza distinta a las verdades establecidas por Newton.
Por supuesto, no tiene sentido juzgar a Garavito por su postura en un contexto particular de hace más de un siglo. Más allá de las influencias filosóficas que hayan existido, consideremos que la mecánica newtoniana es efectivamente una elegante y poderosa caja de herramientas para comprender el universo, que ya para ese tiempo mostraba falencias pero que podía ser mejorada, pulida constantemente por los trabajadores de la ciencia como Garavito, quien ciertamente se dedicó a ello durante toda su vida. Es comprensible que existiera resistencia a abandonar el mundo clásico para dar ese salto incierto que la relatividad demandaba. Garavito falleció con sólo 55 años, al parecer por complicaciones ocasionadas por una tuberculosis. No sabemos qué hubiera pasado si hubiera vivido algunas décadas más, si la Luna lo habría continuado inspirando, quizá, para cambiar de opinión. Pero muy probablemente hubiera continuado trabajando con la constante y absoluta pasión con la que siempre lo hizo.
Referencias
- Los ingeniero-matemáticos colombianos del siglo XIX y comienzos del XX. Las tesis para ser Profesor en Ciencias Matemáticas. Facultad de Matemáticas e Ingeniería 1891-1903. Clara Helena Sánches. Universidad Nacional de Colombia. Facultad de Ciencias, Bogotá. ISBN: 978-958-701-843- 1. 2007.
- ¿Por qué Garavito?. Charla de Bernardo Mayorga, The 1st Colombia-ICRANet Julio Garavito Armero Meeting, Bucaramanga, 2015. Bogotá, Colombia.
-
Fórmulas definitivas para el cálculo del movimiento de la luna por el método de Hill-Brown y con la notación usada por Henri Poincaré en el Tomo III de su curso de Mecánica Celeste. Julio Garavito Armero. Rev. Acad. Colomb. Cienc. Ex. Fis. Nat. 1945, 6 (24):560-570. http://dx.doi.org/10.18257/raccefyn.568
-
Garavito Armero, J. (2017). Fórmulas definitivas para el cálculo del movimiento de la luna por el método de Hill-Brown y con la notación usada por Henri Poincaré en el Tomo III de su curso de Mecánica Celeste. Rev. Acad. Colomb. Cienc. Ex. Fis. Nat., 41(Suplemento), 80-91. https://doi.org/10.18257/raccefyn.568
-
Wilson, Curtis. The Hill-Brown theory of the moon’s motion.
Its coming-to-be and short-lived ascendancy (1877–1984). With an appendix of undated pages from a file of George William Hill. Sources and Studies in the History of Mathematics and Physical Sciences. Springer, New York, 2010. -
Jacques Féjoz. The N-body problem. Celestial Mechanics (ed. Alessandra Celletti). EOLSS publishers, Oxford. 2015. https://www.ceremade.dauphine.fr/~fejoz/Articles/Fejoz_2014_nbp.pdf
-
Richard Montgomery. The Three-Body Problem. ScientificAmerican. August 2019.
-
Editorial, Rev. Acad. Colomb. Cienc. Ex. Fis. Nat. 44(170): 9-13, enero-marzo de 2020.
-
Sobre las geometrías no euclidianas: Notas históricas y bibliográficas. Francisco José Duarte Isava. Rev. Acad. Colomb. Cienc. Ex. Fis. Nat. 1946, 7 (25-26): 63-81.
-
El positivismo en la física moderna y la evolución de la ciencia. Jorge Álvarez Lleras. Conferencia del curso de extensión universitaria, Universidad de Bogotá, enero 1937.
-
Gabriel Poveda Ramos. Historia de las matemáticas en Colombia. Ediciones UNAULA 2012.
Sobre el autor: Alberto Mercado Saucedo es profesor de matemáticas en la Universidad Técnica Federico Santa María (Valparaíso, Chile)
El artículo Julio Garavito, con la mirada en la Luna se ha escrito en Cuaderno de Cultura Científica.
Entradas relacionadas:- Una mirada topológica al conjunto de Cantor
- Otra mirada al planeta: arte y geología
- La pandemia desde una mirada infantil
Beren planetak irensten dituzten izarrak
2009
Osaketa kimikoan abiatuta, astronomo talde batek kalkulatu du Eguzkiaren antzekoak diren izarren laurden batek planetaren bat ‘irentsi’ izanaren zantzuak erakusten dituela.
Ohiko irudia da unibertsoari buruzko dokumental eta erreportajeetan: astro batek bestea irensten duenekoa. Irudi harrigarriak dira, zalantza izpirik gabe, kasu gehien-gehienetan irudikapen artistikoak diren arren. Baina irudimena pizteko modukoak dira. Neutroi izar batek bikotekidea irensten, edo bi zulo beltz talka egiten, adibidez. Izar batek planeta bat irensten duelako irudia ez dago agian horrenbeste zabalduta, seguruenera izarraren aldean planetak erakusten duen txikitasunagatik edo. Baina perspektiba kontua da, noski. Planeta horretan egonez gero, zaila litzateke egoeraren tamainari neurria ez hartzea.

Irudi hori, baina, uste baino ohikoagoa izan daiteke unibertsoan, gaiaren bueltan egin den azken ikerketa bati kasu eginez bederen. Nature Astronomy aldizkarian argitaratutako artikulu batean (hemen, irekian ) proposatu dutenez, Eguzkiaren antzekoak diren izarren artean, gutxi gorabehera laurden batek haren inguruko planetaren bat irentsi du.
Gure Eguzki-sistemaren inguruan daukagun esperientziatik abiatuta, lehen kolpe batean bederen zaila da pentsatzea fenomeno hori gerta daitekeela. Izan ere, gure auzo kosmikoan, planeten lerrotzea nahiko ordenatua dirudi. Eguzkitik gertuen daude arrokazko planetak: Merkurio, Artizarra, Lurra eta Marte. Ondoren, gas erraldoiak: Jupiter eta Saturno. Azkenik, izotz planetak: Urano eta Neptuno. Handik harago, gure ezagutza nahiko mugatua da, baina jakin badakigu izotzez osatutako planeta nano eta bestelako objektuak badirela, Kuiper gerrikoan eta Oorten hodeian.
Horregatik, hasiera batean uste zen beste eguzki-sistemek antzeko hurrenkera izango zutela. Behaketek bestelako irudi bat eman dute, ordea. Azken hamarkadetan zehar aurkitu diren exoplanetei esker, jakin badakigu mota askotako eguzki-sistemak badirela Esne Bidean. Adibidez, Jupiter beroak aurkitu dira beren izarretik nahiko gertu. Izar bakar batez ez baizik bi izarrez osatutako sistema bitarrak oso ohikoak dira, eta, muturretara joanda, sei izarrez osatutako sistemak ere aurkitu dira. Funtsean, hein handi batean, eguzki-sistemen ezaugarriak izar bakoitzaren edo izar multzo bakoitzaren araberakoa da.
Bestetik, planetak hain dira zailak atzemateko ezen astronomoek gehienetan izarren argira jo behar baitute mundu urrun horien inguruko informazioa jasotzeko. Oraingo ikerketan horrela izan da ere. Izarren espektroari erreparatu diote. Zehazki, Eguzkiaren antzekoak diren 107 izar sistema bitar aztertu dituzte. Bikote horietatik, 74k antzeko osaketa kimikoa dute. Gainerako 33 sistematan, berriz, izar baten burdin eta litio kontzentrazioak bikotearenak baino dezente handiagoak dira.
Aukeraketa egiterakoan, antzeko masa eta tenperaturak dituzten sistema bitarrak aukeratu dituzte, horiek izar biki gisa hartu ahal izateko. Bestetik, sistema bitarrak aztertu izanak azalpen garbia du. Gure Eguzkia G motako izarra da. Esne Bideko izarren %7 inguru horrelakoak dira. Baina Eguzkia oso berezia da beste aldagai batean. Horrelako izarrak normalean bitarrak izaten dira, hau da, bikoteka azaltzen dira, masa zentro baten inguruan biraka.
Bikoteka eta jatorrizko material beretik jaiota, zentzuzkoena da pentsatzea izar biki hauen osaketa kimikoa berdina izan beharko zela, baina, behaketek erakutsi dute hau ez dela beti horrela. Hortaz, zientzialariek aurretik bazekiten Eguzkiaren antzekoak diren izarren artean badirela aldeak osaketa kimikoari dagokionez. Desberdintasun horrek azalpenaren bat izan behar du, eta horren bila joan dira oraingoan astrofisikariak.
Eta hau azaltzeko, orain arte bi teoria jarri dira mahai gainean. Lehen aukera da planeten eta izarren sorrera ahalbidetu zuen jatorrizko gas hodeian desberdintasun kimikoak egon izana. Bigarren aukera da izarrak planetak irentsi izana, eta handik eskuratu izana osaketa kimiko berezia. Hipotesi honen alde “froga sendoak” aurkeztu dituzte orain, zientzia artikuluan bertan ikertzaileek aldarrikatu dutenaren arabera. Ondorioz, ikertzaile hauek uste dute G motako izarren portzentaje batek (probabilitatea %20-%35 tartean kokatu dute) planetaren bat bereganatu duela. Osaketa kimikoa desberdina horren zantzua litzateke.

Oro har, izarren osaketa kimikoa nahiko sinplea da. Haien bizitzaren zati handienean bederen hidrogenoa eta helioa dituzte batez ere, eta baita oxigenoa eta karbonoa. Zahartu ahala, elementu horiek “erre” eta eraldatzen doaz, taula periodikoan aurrera eginez. Arrokazko planetek, berriz, elementu pisutsuak dituzte haien osaketa kimikoan, eta, horregatik, izarraren kontra jotzen dutenean, elementu hauen aztarnak sartzen dira izarrean. Hori gertatzeko, litekeena da bi planeten arteko grabitazio tira-birak gertatu izana, eta, ondorioz, horietako bat izarrera amildu izana, edo izarretik hain gertu geratzea ezen pixkanaka planeta gizajoa guztiz lurrunduta geratu baita.
Ikusi dute ere beroen dauden izarretan aukera gehiago dagoela irenste hauen zantzuak aurkitzeko. Beroenek kanpoko geruza meheagoak dituzte, eta horrek aukera ematen du planetek haien heriotzan utzitako zantzu kimikoak hobeto atzemateko. Burdin gehiago ez ezik, litio gehiago dute ere, eta hau oso adierazgarria dela azaldu dute. Izan ere, litioa nahiko azkar desagertzen da izarretan, baina planetetan aise kontserbatzen da. Horregatik uste dute litio hori irenste prozesu horren arrastoa dela ere.
The Conversation atarian argitaratutako artikulu batean Lorenzo Spinoza astrofisikariak azaldu du ikerketaren muina: “Gure eguzki-sisteman, Eguzkiaren inguruan biratzen dute planetek, modu egonkor eta ia-ia zirkularrean, eta horrek iradokitzen du orbitak ez direla asko aldatu planetak eratu zirenetik. Baina beste izarren inguruan orbitatzen duten beste sistema planetario askok oso iragan kaotikoa izan dute”.
Eguzki-sistemaren historia nahiko lasaia suertatu izanak bultzatu du bizitzaren agerpena Lurrean. Horregatik, beste sistema planetario urrunetan bizia bilatzerakoan, astrofisikariek uste dute ataza errazagoa izango dela baldin eta jakin badakigu identifikatzen zentzuk izan diren antzeko iragan lasaia izan duten sistema planetarioak. Ikertzaileek argudiatu dutenez, garatu duten metodoari esker errazagoa izango da identifikatzea zenbait eguzki-sistema: Lurraren atzekoak diren planetak izateko moduko baldintzak ez dituztenak, alegia.
Erreferentzia bibliografikoa:Spina, L., Sharma, P., Meléndez, J. et al. (2021). Chemical evidence for planetary ingestion in a quarter of Sun-like stars. Nature Astronomy. DOI: https://doi.org/10.1038/s41550-021-01451-8
Egileaz:Juanma Gallego (@juanmagallego) zientzia kazetaria da.
The post Beren planetak irensten dituzten izarrak appeared first on Zientzia Kaiera.
Microorganismos, sin ellos, usted no estaría leyendo este artículo
Ignacio López-Goñi y Víctor Jiménez Cid
Shutterstock / luchschenF
Cada 17 de septiembre se celebra el Día Internacional de los Microorganismos. Dicha celebración parece contradictoria en medio de una pandemia, como si algo bueno pudiera salir de estos seres vivos. Los gérmenes nos causan enfermedades e incluso la muerte, pero no permitamos que el árbol no nos deje ver el bosque: la inmensa mayoría de los microorganismos son buena gente. Es más, son necesarios para nuestra supervivencia y la todos los ecosistemas del planeta, así que se merecen que celebremos su día.

Wikimedia Commons / WikiProject Royal Society / Mike Peel
Pero, ¿por qué el 17 de septiembre?
Probablemente el 17 de septiembre de 1683 amaneció frío y lluvioso en la pequeña ciudad holandesa de Delft, famosa por sus canales. Anton van Leeuwenhoek, comerciante de telas primero y luego empleado municipal, sin formación científica alguna, decidió ese día enviar una carta que cambiaría el curso de la ciencia. En aquella misiva, dirigida a la Royal Society de Londres, describía por primera vez los microorganismos, formas de vida microscópicas aparentemente simples que él denominó “animálculos”.

Wikimedia Commons, CC BY
Leeuwenhoek era aficionado a construir pequeñas lupas que los comerciantes empleaban para analizar la calidad de los tejidos. Pulía sus propias lentes biconvexas que fijaba entre dos hojas de latón y sostenía muy cerca del ojo. Las muestras se colocaban sobre una especie de alfiler, que se podía acercar o alejar de la lente para enfocar mediante unos tornillos. Tenía tal habilidad para pulir lentes que sus lupas llegaban a alcanzar más de 250 aumentos y un poder de resolución (capacidad para diferenciar entre dos puntos muy próximos entre sí) de 1,5 micras. Esto alcanza casi la resolución de un moderno microscopio óptico. Fue, por tanto, la primera persona que logró observar bacterias y otros microorganismos.

Wikimedia Commons, CC BY
En realidad, Leeuwenhoek no inventó el microscopio. Probablemente fue otro holandés, Zacharias Janssen (1588-1638), quien construyó el primero, compuesto de dos lentes. Este consistía en un simple tubo de unos 25 cm de longitud y 9 cm de ancho con una lente convexa en cada extremo.
El inglés Robert Hooke (1635-1703), contemporáneo de Leeuwenhoek, publicó en 1665 el libro Micrographia, donde describía las observaciones que había llevado a cabo con un microscopio similar al de Janssen diseñado por él mismo. Este libro contiene por primera vez la palabra “célula”. Hooke las descubrió observando en su microscopio una lámina de corcho, dándose cuenta de que estaba formada por pequeñas cavidades poliédricas que recordaban a las celdillas de un panal.
Sin embargo, aquellos microscopios compuestos eran solo una lupa capaz de conseguir unos pocos aumentos. Ni Janssen ni Hooke fueron capaces de observar lo que poco después describiría Leeuwenhoek usando una sola lente.
El mundo de los microorganismos estuvo oculto para la ciencia hasta que Leeuwenhoek decidió enfocar con su microscopio más allá de los tejidos y telas de su comercio.

Wikimedia Commons
Leeuwenhoek fue el primero en ver los glóbulos rojos y los espermatozoides. Sus dibujos de bacterias publicados en 1684 son de una excelente calidad y nos permiten reconocer varios tipos de bacterias frecuentes y sus agrupaciones: bacilos, cocos, etc.
Fue muy celoso con sus microscopios. No compartió con nadie su forma de pulir o tallar las lentes y no dejó ninguna indicación sobre sus métodos de fabricación. Destruyó la mayoría de sus creaciones, de las que actualmente solo se conserva una docena. Uno de ellos está expuesto hasta el 8 de diciembre en el Museo Nacional de Ciencias Naturales de Madrid, con motivo de la exposición “Explorando más allá de lo visible” que organiza la Sociedad Española de Microbiología con motivo de su 75 aniversario.
Los primeros habitantes del planeta
La ciencia tardó casi doscientos años en volver a desarrollar una técnica equivalente a la de Leeuwenhoek. Sus observaciones demostraron tres características del mundo microbiano: que está integrado por seres muy pequeños, que están en todas partes y que son muy diversos.
Los microorganismos han tenido y tienen un papel esencial en nuestros ecosistemas. Se estima que hace unos 3 800 millones de años surgió la vida en la Tierra. Desde entonces, hasta la aparición de los primeros seres vivos pluricelulares hace unos 900 millones de años, el planeta solo ha estado habitado por seres microscópicos. Bacterias, arqueas, virus y microorganismos más complejos pero unicelulares.
Esto supone que, durante unos 2,9 millones de años, han sido los únicos habitantes del planeta. Nos han precedido y muy probablemente seguirán aquí cuando nuestra especie desaparezca.
Han sido responsables de grandes cambios a nivel planetario: hasta la aparición de las cianobacterias (un tipo de microorganismos que llevan a cabo una fotosíntesis que genera oxígeno) hace unos 2,8 millones de años, la Tierra era un ambiente anaerobio. El oxígeno atmosférico es un invento de los microorganismos. Por tanto, no solo la vida en la Tierra ha sido y será fundamentalmente microbiana, sino que los seres más complejos, plantas y animales hemos evolucionado a partir de ancestros microbianos en una biosfera modificada y condicionada por su actividad.

Wikimedia Commons, CC BY
Cuando hablamos de conservación de la biodiversidad en el planeta, no debemos olvidar que el grueso de la biodiversidad en la Tierra es invisible. Estas formas de vida diminutas han llegado a colonizar prácticamente todos los ecosistemas terrestres y son capaces de sobrevivir a las condiciones más extremas. Incluso donde a primera vista la vida es imposible: Geogemma barossi es capaz de sobrevivir a 121 ⁰C en chimeneas hidrotermales en las profundidades marinas. La bacteria Psychromonas ingrahamii se aísla de ambientes polares y crece a temperaturas de -12 ⁰C. Picrophilus oshimae fue aislada de fumarolas volcánicas a un pH ácido de 0,7. Halobacterium salinarum se aísla por ejemplo del Mar Muerto a concentraciones de sal saturantes, incompatibles con otras formas de vida.
¡Están por todas partes! Se han aislado hongos microscópicos y bacterias en capas altas de la atmósfera, a más de 15 km de altura. Se encuentran en las profundidades marinas a más de 10 000 metros de profundidad e incluso a varios cientos de metros bajo la superficie terrestre.
El 90 % de la biomasa marina es microbiana y son responsables de la mitad del CO₂ fijado y de la mitad del O₂ producido. Por eso, también los microorganismos pueden influir en el cambio climático y viceversa: cambios de temperatura y humedad pueden alterar la biología de estos seres vivos y, a su vez, eso puede cambiar las condiciones del hábitat.
El suelo que pisamos, sin ir más lejos, es uno de los ecosistemas más complejos. Se calcula que un gramo de suelo puede contener más de 10 000 millones de microorganismos, más que seres humanos tiene el planeta. Son responsables de completar todos los ciclos biogeoquímicos de la materia. Por ejemplo, realizan la fijación del nitrógeno atmosférico (en simbiosis con las leguminosas o de vida libre en el suelo) y lo transforman en amonio, nitrito y nitrato. Sin microorganismos no existiría el ciclo del nitrógeno, esencial para la vida tal y como la conocemos.

Wikimedia Commons / William Hickey, CC BY-SA
Aunque suene drástico, es muy probable que la extinción del pingüino emperador (aunque sea una pérdida de valor incalculable) no suponga el colapso del planeta, pero la extinción de bacterias como Nitrosomonas o Nitrobacter, que intervienen en el ciclo del nitrógeno, supondría el colapso inmediato de la vida. En esencia, sin microorganismos la vida macroscópica que apreciamos a simple vista, nuestra propia vida, no sería posible.
Medio humanos, medio microbios
Hoy en día las nuevas técnicas de metagenómica (secuenciación masiva), que superan los métodos tradicionales del cultivo, nos permiten comprobar la enorme biodiversidad microbiana que se oculta en la naturaleza.
Los científicos conocemos con cierto detalle la biología de mucho menos del 1 % de los microorganismos que realmente existen. El hábitat de muchos de ellos es la superficie o el interior de otros seres vivos. Es lo que conocemos como la microbiota de las plantas, de los animales o del ser humano. Nosotros mismos somos mitad humanos, mitad microorganismos: por cada una de nuestras células humanas, tenemos al menos una célula microbiana. Están en nuestra piel y en todas nuestras mucosas: en la boca, en los intestinos, en la vagina, en las vías respiratorias, etc.
Somos un conjunto ambulante de ecosistemas microbianos en los que se producen multitud de interacciones entre nuestras células y los microorganismos. El equilibrio de estos ecosistemas es esencial para nuestra salud. Estos diminutos seres evitan la colonización de nuestra piel y mucosas por otros microorganismos patógenos. Estos forasteros deben recurrir a complejos mecanismos de virulencia para imponerse en un entorno bien defendido por los colonos.
Los microorganismos que forman nuestra microbiota ayudan a mantener la barrera intestinal y contribuyen a la digestión degradando sales biliares, proteínas y polisacáridos. También modulan y entrenan a nuestro sistema inmunitario, regulan los procesos inflamatorios, sintetizan vitaminas y otros compuestos necesarios para nuestra salud, degradan drogas y toxinas o producen neurotransmisores y hormonas.
Cuando ese equilibrio entre nuestros microbios y nuestro organismo se altera (disbiosis) se pueden producir patologías.
La caries dental y la periodontitis son ejemplos directos de “problemas diplomáticos” con nuestra microbiota, pero recientemente se ha descrito la relación de múltiples patologías con una alteración de nuestra microbiota: desde la obesidad, diabetes, alergias, asma, enfermedades inflamatorias, hasta la depresión, el alzhéimer e incluso el autismo.
Así, la medicina del siglo XXI cuenta con un nuevo sistema en el cuerpo humano esencial para la salud: la microbiota. Del mismo modo, cuando estudiamos la función del genoma humano, no debemos pasar por alto que el sistema se completa con el microbioma, el conjunto de genes codificados en los genomas de los cientos de especies microbianas que forman parte de nosotros. La ecología microbiana entra en la ecuación de nuestro bienestar y la biomedicina se enfrenta a nuevos retos.
Levadura, yogur, queso y PCRs
Si a alguien le parecen aún pocos los motivos, añadiremos que gracias a los microorganismos nuestra vida es más fácil e incluso más agradable. Saccharomyces, la levadura que se utiliza ancestralmente en fermentaciones alimentarias, es un hongo unicelular gracias al cual tenemos en la mesa pan, cerveza y vino.
Lácteos como el yogur y el queso son fruto de la fermentación bacteriana. Alimentos y bebidas fermentadas, antibióticos, enzimas, vitaminas, hormonas, aminoácidos (aditivos, edulcorantes, antioxidantes…) son productos del metabolismo de los microorganismos. La biotecnología cuenta también con ellos para la producción de energía verde, el control de plagas, el bienestar animal y la descontaminación.

Wikimedia Commons / Diane Montpetit (Food Research and Development Centre, Agriculture and Agri-Food Canada)
La famosa técnica de la PCR que ha sido un elemento esencial durante la pandemia es posible gracias a una enzima termoestable que se obtiene de Thermus aquaticus,una de esas bacterias capaces de sobrevivir a altísimas temperaturas.
Hoy somos capaces de modificar microorganismos en el laboratorio para que fabriquen todo tipo de medicamentos o productos esenciales en biomedicina y biotecnología. Podemos emplearlos para desarrollar plantas transgénicas capaces de resistir a la sequía, para producir biocombustibles, para degradar compuestos contaminantes, e incluso emplearlos como vacunas para controlar una pandemia.
En aquella famosa carta del 17 de septiembre de 1683 se realizó una descripción exquisita de la primera observación de bacterias vivas presentes en la placa dental, acompañada por dibujos de los microorganismos observados y sus movimientos. Ese día comenzó una nueva era para la ciencia que tardaría dos siglos, ya en tiempos de Louis Pasteur y Robert Koch, en desarrollarse como disciplina científica, y nos permite conocer y estudiar el mundo de los microorganismos, que tanta influencia tiene en nuestro planeta. Vivimos en un mundo microbiano.
Celebre con nosotros el Día Internacional de los Microorganismos.
Sobre los autores: Ignacio López-Goñi es Catedrático de Microbiología de la Universidad de Navarra y Víctor Jiménez Cid es Catedrático de Microbiología de la Universidad Complutense de Madrid
Este artículo fue publicado originalmente en The Conversation. Artículo original.
El artículo Microorganismos, sin ellos, usted no estaría leyendo este artículo se ha escrito en Cuaderno de Cultura Científica.
Entradas relacionadas:- Natacha Aguilar: “Necesitamos que el mar esté en equilibrio para que el planeta también lo esté”
- La extinción de la megafauna chilena dejó a este árbol sin ayuda para dispersar sus semillas
- Identificadas 472 posibles dianas inmunes en la interacción planta-microorganismos
Asteon zientzia begi-bistan #360
Asteon zientzia begi-bistan igandeetako gehigarria da. Astean zehar sarean zientzia euskaraz jorratu duten artikuluak biltzen ditugu. Begi-bistan duguna jaso eta laburbiltzea da gure helburua.
Emakumea zientzian
Aste honetan Zientzia Kaieran, genero-arrakalaren inguruko artikulu bat izan dugu, lanaren eta bizitza pertsonalaren arteko orekaren inguruan. Yana Gallen eta Melanie Wasserman ekonomialari laboralen ikerketa baten arabera, emakumezko ikasleek askoz ere bat-bateko informazio gehiago jasotzen dute lanaren eta bizitza pertsonalaren arteko bateragarritasunaren inguruan gizonezkoek baino. Eskatu gabe emandako informazioa da eta gizonezkoekin alderatuta probabilitatea bikoitza baino gehiago dute informazio hori jasotzeko.
IngurumenaIkerketa batek lehen aldiz frogatu du suteetan sortutako aerosolek itsasoa ongarritu dezaketela eta horren ondorioz, algen ezohiko loratze handiak sortu. Halaxe gertatu zen Ozeano Antartikoan, 2019-2020an Australian izan ziren sute erraldoien ondoren. Nature aldizkarian argitaratu dituzte emaitzak, eta, fitoplaktonaren hazkundea aireko karbono dioxidoarekin erlazionatu dute. Izan ere, litekeena da algek, neurri batean, suteek askatutako CO2-a xurgatzea, fotosintesia egiteko. Datu guztiak Elhuyar aldizkariko Australiako suteek Ozeano Antartikoan algak neurriz kanpo ugaritzea ekarri dute artikuluan.
Ostreopsis cf. siamensis mikroalgak arazoak sortu ditu aste honetan Donostian ere. Abuztuan Lapurdin hondartza batzuk itxiarazi eta gero, oraingoan Gipuzkoako hiriburuko uretan azaldu da. Ez da lehenengo aldia honakorik gertatzen dela, baina oraindik ez dakigu gauza handirik, oraindik deskribatuta ez dagoen Ostreopsis generoko mikroalga bati buruz ari baikara. Hala ere, Aitor Laza EHUko biologoak aitortu duenez, uraren tenperaturaren igoerarekin eduki dezake erlazioa gertaera honek. Datu guztiak Garan: klima larrialdia, ate joka euskal herriko kostaldean artikuluan.
OsasunaZientzia Kaieran irakur daitekeenez, minbiziaren kontrako tratamendu alternatibo bat agertu da, argiak zuzendurikoa. Minbizia tratatzeko erabiltzen diren metodo terapeutiko ohikoenak albo-efektu kaltegarriak dauzkate gizakien osasunean eta horregatik, ahalegin ugari egiten ari dira horren kontra egiteko metodo eraginkor eta selektiboagoak aurkitzeko. Ildo honetatik terapia fotodinamikoa (TFD) agertu da etorkizun handiko alternatiba bezala.
Elhuyar aldizkarian irakur daitekeenez, SARS-CoV-2arekiko immunitate zelularra detektatzeko test erraz bat garatu dute Kanarietako Unibertsitate Ospitalean. Larruazaleko test erraz eta merkea da, tuberkulinarena bezalakoa: S proteinaren zati bat injektatzen da larruazalean, eta erreakziorik sortzen ote duen ikustea besterik ez da. Denborarekin antigorputzak desagertzen joaten dira eta beraz, antigorputz-testak ez dira nahikoak immunitate-maila neurtzeko. Larruazaleko testak, berriz, T linfozitoak detektatzen ditu eta aurrez izandako infekzioak edo txertoak emandako immunitate-maila adieraziko digu.
COVID-19 larria garatu eta ospitalean amaitzen duten pazienteek, antigorputzez gain, autoantigorputzak ere sortzen dituztela azaltzen du Elhuyar aldizkariak. Hori da, hain zuzen ere, COVID-19 larria garatzearen arrazoia. Gaixotasun autoimmuneetan bezala, autoantigorputz horiek birusari aurre egiten dioten antigorputzen aurka jotzen dute eta hala, antigorputzek ezin diote infekzioari aurre egin. Stanfordeko Unibertsitatean egindako ikerketa batean ohartarazi denez, autoantigorputz hauek, COVID-19 larria garatzeaz gain, pazienteek etorkizunean benetako gaixotasun autoimmune bat garatzea ere eragin dezakete. Aitziber Agirrek kontatzen du Elhuyar aldizkarian: COVID-19 larriaren mekanismoa argitu dute.
GenetikaGiza geneak izendatzen dituen erakundeak 27 generi izena aldatu die, Excel edo Google Sheets programa ospetsuen autozuzentzaileek sortzen zituzten arazoak saihesteko. Autozuzentzaileek uste dute SEPT4 edo MARCH1 geneak datak direla eta “irailak 4” edo “martxoak 1” izenpean gordetzen dituzte. Arazoa oso hedatuta dago: Lan berri batean 11.000 artikulurekin batera eskuragarri jarri diren kalkulu-orriak aztertu dira, eta horien heren batean akatsak aurkitu dira geneen izenetan. Orain, SEPT4 genea SEPTIN4 izendatzen da eta MARCH1, berriz, MARCHF1. Datu guztiak Koldo Garcia genetistak eman dizkigu Zientzia Kaierako Akatsek genetikaren ikerkuntza oztopatzen dutenean artikuluan.
TeknologiaLitio-ioi baterien arazoen inguruan idatzi du aste honetan Imanol Landa kimikariak eta Zientzia Kaierako kolaboratzaileak. Bateria hauen hastapenetan nabarmendu ziren hiru ikertzailerik 2019 urteko Kimika Nobel saria irabazi zuten, auto elektrikoek erabiltzen dituzten bateriak baitira. Imanolek ordea, zalantzan jartzen du sari honek ezkutuko interesik ba ote duen, autogintzarena hain zuzen. Argi esaten du: ingurumen-inpaktua gutxi murriztuko da auto elektrikoen erabilerarekin, auto hauen bateriak kargatzeko egungo energia ekoizte-ereduari eusten badiogu. Azalpenak Zientzia Kaieran: Litio-ioi bateriak: irtenbidea edo arazo berria?
ArkeologiaArropagintza duela 120.000 urte hasi zela argitu dute Max Planck Institutuko arkeologoek, Marokon aurkitutako hezur-erreminta batzuei esker. Erreminta gisa erabiltzeko moldatutako 60 hezur baino gehiago aurkitu dituzte Contrebandiers izeneko kobazuloan, eta duela 120.000-90.000 urtekoak zirela frogatu dute. Erreminta horietako asko, arropagintzarako erabiltzen zituztela ondorioztatu dute, hezurrek dituzten markak aztertuta. Aitziber Agirrek kontatzen du Elhuyar aldizkarian.
Egileaz:Irati Diez Virto Biologian graduatu zen UPV/EHUn eta unibertsitate bereko Kultura Zientifikoko Katedrako kolaboratzailea da.
The post Asteon zientzia begi-bistan #360 appeared first on Zientzia Kaiera.
La ría y el metro

Construir un metro en una ciudad nunca es cosa fácil. Si encima hay que atravesar una ría como la del Nervión por debajo la ingeniería tiene que ser muy creativa. En este vídeo se resume los hitos técnicos de como se construyeron los tramos que atraviesan la ría de Metro Bilbao.
Edición realizada por César Tomé López
El artículo La ría y el metro se ha escrito en Cuaderno de Cultura Científica.
Entradas relacionadas:- Evolución de la flora y fauna en el Abra de Bilbao
- La ría de Bilbao como medio de transporte de mineral
- Poesía métrica, ¿de metro?
Ezjakintasunaren kartografia #365
CXCR4 as a therapeutic target in cancer artikuluan, ingurune mikroseinaleei kaltzineurina izeneko proteina baten aktibitatearen eta zelula leuzemikoen artean dagoen harremana azaltzen du Marta Irigoyenek.
José R. Pinedak When the inhibition of the inhibitory signals results in an exacerbated response. The case of IL-13 and the COVID-19 severity artikuluan azaltzen du covid-19aren larritasunak zelulen arteko komunikazioarekin harremana duela.
Mikroelektronika monomolekularrean aplikazioa izan ditzaketen material organikoen alorrean, DIPCk apaldu egiten du garrantzitsutzat hartutako aurkikuntzari: benetan handia den nanoeraztun aromatikoa: The large aromatic nanoring that wasn’t
Mapping Ignorance bloga lanean diharduten ikertzaileek eta hainbat arlotako profesionalek lantzen dute. Zientziaren edozein arlotako ikerketen azken emaitzen berri ematen duen gunea da. UPV/EHUko Kultura Zientifikoko Katedraren eta Nazioarteko Bikaintasun Campusaren ekimena da eta bertan parte hartu nahi izanez gero, idatzi iezaguzu.
The post Ezjakintasunaren kartografia #365 appeared first on Zientzia Kaiera.
La fluorescencia de la clorofila y el estudio de la Tierra como un sistema
¿Cuánto dióxido de carbono atmosférico asimila realmente un bosque por fotosíntesis? ¿Qué variedades de plantas son menos sensibles al cambio climático global? Responder a esas preguntas ahora podría ser posible mediante la observación de la fluorescencia de la clorofila.

La clorofila, el pigmento verde presente en plantas y algas que permite captar la luz del sol, emite una luz roja tenue durante la fotosíntesis. Esa denominada “fluorescencia de la clorofila”, que no vemos en condiciones normales debido al reflejo de otros colores de la luz incidente, especialmente el verde, transmite información sobre la tasa instantánea de fotosíntesis, lo que proporciona una «ventana óptica» que rastrea el estado funcional y de salud de la planta. Una reciente investigación en el que ha participado José Ignacio García Plazaola, del grupo de investigación Ekofisko del Departamento de Biología Vegetal y Ecología de la UPV/EHU, describe la conexión existente entre esta fluorescencia y el estudio de la Tierra como un sistema.
Aunque se conocen desde hace décadas diferentes métodos de laboratorio y de muestreo en el campo que permiten medir e interpretar la fluorescencia de la clorofila en una hoja o a nivel subcelular, solo recientemente se puede medir la fluorescencia de la clorofila inducida directamente por el sol (SIF), y obtener imágenes en un ecosistema y a escalas regionales.
Las mediciones actuales de SIF se realizan con sensores ópticos montados en torres, drones, aviones e, incluso, satélites. En este sentido la misión FLuorescence EXplorer (FLEX) de la Agencia Espacial Europea lanzará un satélite en 2024 que proporcionará mapas globales de SIF con una resolución de unos pocos cientos de metros.
Esos desarrollos allanan el camino para múltiples aplicaciones científicas y comerciales en ecofisiología vegetal, ecología, biogeoquímica, así como para la agricultura de precisión y silvicultura.
«Estas herramientas abren la puerta a la realización de estudios de fotosíntesis espacial y 3D en el campo, lo que ayudará a resolver cuestiones relacionadas con la dinámica fotosintética de las diferentes partes de una planta o ecosistema en condiciones del mundo real. SIF también se puede aplicar en fenotipado fisiológico y detección pre-visual de estrés, que es una herramienta poderosa para las prácticas de manejo de cultivos y bosques de próxima generación”, explica José Ignacio García Plazaola.
Para cumplir con esos ambiciosos objetivos, se requieren estudios colaborativos multidisciplinarios y a múltiples escalas. La experiencia de la biología vegetal, la teledetección, la agronomía y la silvicultura deben fusionarse para traducir el contenido de información de SIF en aplicaciones innovadoras que aprovechen el conocimiento a través de las escalas molecular, foliar (las hojas) y del dosel (la parte superior de los árboles visible desde arriba).
Referencia:
Albert Porcar-Castell, Zbyněk Malenovský, Troy Magney, Shari Van Wittenberghe, Beatriz Fernández-Marín, Fabienne Maignan, Yongguang Zhang, Kadmiel Maseyk, Jon Atherton, Loren P. Albert, Thomas Matthew Robson, Feng Zhao, Jose-Ignacio Garcia-Plazaola, Ingo Ensminger, Paulina A. Rajewicz, Steffen Grebe, Mikko Tikkanen, James R. Kellner, Janne A. Ihalainen, Uwe Rascher & Barry Logan (2021) Chlorophyll a fluorescence illuminates a path connecting plant molecular biology to Earth-system science Nature Plants doi: 10.1038/s41477-021-00980-4
Edición realizada por César Tomé López a partir de materiales suministrados por UPV/EHU Komunikazioa
El artículo La fluorescencia de la clorofila y el estudio de la Tierra como un sistema se ha escrito en Cuaderno de Cultura Científica.
Entradas relacionadas:- Saturno tiene el sistema de nieblas en capas más extenso observado en el Sistema Solar
- Puntos cuánticos encapsulados con fluorescencia de meses
- Las lapas como indicador paleoclimático de alta resolución
Alferreko aholkuak emakumezko unibertsitarioei
Emakumeek bi aldiz probabilitate gehiago dute, eskatu gabe ere, lana eta bizitza pertsonala bateragarri egiteari buruzko aholkuak jasotzeko. Hala gertatzen da unibertsitate ikasleek profesionalen bidez informazioa informalki bilatzen dutenean. Lan munduarekin harremanetan jartzeko modu bat da, eta enplegu aukerak ezagutzen lagundu diezaieke. Graduatu berri diren hautagaiek edo unibertsitateko ikasketen azken urteetan sareak zabaldu ahala, kontsulta informal horiek eragina izan dezakete itxaropen eta hautu profesionaletan.
Hala ere, ikasleen eta profesionalen arteko lotura guztiak ez dira berdinak, Yana Gallen eta Melanie Wasserman ekonomialari laboralen azterketa baten arabera. Ikerketa horrek erakutsi zuen emakumezko ikasleek gizonezko ikasleek jasotzen dituzten mezuez bestelakoak jaso ohi dituztela. Mezu horietan, lanaren eta bizitza pertsonalaren arteko orekak duen garrantzia azpimarratzen zaie (Gallen eta Wasserman, 2021). Hala, modu subliminalean edo esplizituan, konbentzitu egiten dituzte emakumeak lanbide ibilbide batzuk edo besteak aukeratzeko, haien prestakuntza akademikorako onenak izan daitezkeen kontuan hartu gabe.

Azterlana Becker Friedman Ekonomia Institutuak argitaratu zuen, eta eskala handiko landa esperimentu baten emaitzak aztertu zituen; esperimentu hartan, unibertsitate ikasleek mezuak telematikoki bidali zizkieten aktibo zeuden 10.000 profesionali, etorkizuneko enpleguen inguruko orientazioa eta aholkua eskatzeko. Gizonezko eta emakumezko igorleak ausazko prozesuan sartzean, Gallen eta Wassermanek frogatu nahi zuten generoak ikasle batek jasotzen zuen informazio motan eraginik zuen. Erantzuna argia izan zen: bai.
«Ikasleek enplegu ibilbide jakinei buruzko enpresa, negozio edo erakundeetako profesionalen informazio orokorra bilatzen dutenean, emakumezko ikasleek askoz ere bat-bateko informazio gehiago jasotzen dute lanaren eta bizitza pertsonalaren arteko orekaren inguruan gizonezkoek baino», azaldu zuen Gallen, soldatako genero-arrakalan adituak. «Profesionalek emakumeei lana eta bizitza pertsonala bateragarri egiteko kontuei buruzko informazioa emateko probabilitatea bikoitza baino gehiago da; alde hori nahiko dramatikoa da».
Ikerketa da nagusietako bat horretan, ikaslearen generora egokitzen baita ezaugarri profesional jakin batzuei buruz ematen den informazioa. Gainera, ikasleek, gizonek eta emakumeek, lanaren eta bizitza pribatuaren arteko orekari buruz zehazki galdetu zutenean, emakumezko ikasleek kontu horiei buruzko % 28 erantzun gehiago jaso zituzten, gizonezko ikasleek baino. Hau da, ikasleek lanaren eta bizitza pribatuaren arteko orekari buruz nahita galdetu zutenean, profesionalak luze eta zabalago aritu ziren emakumezko ikasleekin, eta gai horiei buruz hitz egiteko askeago: ikasteko denbora, inplikazioa eta konpromisoa lanarekin; hautatutako lanbidearen eskakizunak, haien aisiaz eta bizitza sozialaz gozatzea eragotziko dietenak; haien zaintza pertsonalerako edo jarduera pribatuetarako denborarik gabe utziko dituzten laneko konpromisoak eta abar. Hala, egiaztatu zuten emakumezko ikasle horiei emandako erantzunetan enfasi gehiago erakutsi izanaren arrazoietako bat dela emakumeek gai horien gaineko interesa duten eta gizonek ez duten ustea, baina profesionalek gizonezko edo emakumezko ikasleekin elkarreraginean jarduteko dituzten antolaera estereotipatuek eta aurreiritziek ere baldintzatzen dutela.
Gallen eta Wassermanek, halaber, emaitza esanguratsu gisa aurkitu zuten lanaren eta bizitza pribatuaren arteko orekarekin zerikusia zuten erantzun gehienak desmotibatzaileak zirela; horrek, aldi berean, ikasleengan kezkak eragin zitzakeen, enplegu bat hautatzeko baliagarriak izan zitezkeen beste informazio batzuk alboratzea ekarriz. Asmoa da emakumezkoei iradokitzea haientzat hain zaila dela bizitza soziala eta pribatua etorkizuneko lanbidearekin uztartzea, ezen onena, agian, haien asmoak birpentsatzea baita. Alferreko informazio horrekin guztiarekin, uler dezakete haien galdera teknikoenak edo euren ezagutzekin lotura dutenak ez direla egokiak; hasieratik sobera baleude bezala, edo, behintzat, hori da enplegu baterako hautagai diren emakumezko gazte askoren pertzepzioa.

Ikerketaren datuek agerian utzi zuten, halaber, emakumezko ikasleak gizonezko ikasleak baino gehiago gogogabetu zirela haien ustez egokia zen lanbide ibilbideari ekiteko asmoan. Ez dute bere buruan konfiantza nahikoa, edo dauzkaten zalantzak haien lan xedeen inguruan profezia sexistek aurresandako emaitza dira?
Ikerketa hau ekonomiako, politikoa publikoetako eta matematikako ikasleen artean eta finantzen, kudeaketaren, datuen zientziaren eta zuzenbidearen eremuetako profesionalen artean egin zen arren, ondorioak beste lan ingurune batzuetara ere orokortu daitezke.
Unibertsitate ikasleek goi mailako ikasketak amaitzean izan ditzaketen aukerei buruz jasotzen duten informazioak pisu handia du haien hautuetan. Hala frogatzen dute ikerketa batzuek, besteak beste, Catherine Porter eta Danila Serra ikertzaileenak; ekonomian espezializatzen diren emakumeen ehunekoa handitzeko helburua jarri zuten, eremu horren barruan unibertsitateko lehen urtea egin ondoren. Lehen mailetan izena emanda zeuden ikasleei unibertsitate berean ekonomian espezializatu ziren emakume karismatikoen hitzaldiak eman zitzaizkien. Hitzaldiek eragin nabarmena izan zuten emakumezko ikasleek ekonomiako beste irakasgai batzuetan matrikulatzeko, eta ekonomian espezializatzeko aukera ehuneko 8 puntu areagotu zen. Inpaktua oso altua izan zen; izan ere, emakumeen % 9 baino ez ziren espezializatzen ekonomian hitzaldien aurretik. Asmoa aldatu zuten emakumeek diru sarrera baxuko eremuetan espezializatzea planeatzen zuten, eta kostu txikiko esku hartze horrek eragin oso positiboa izan zezakeen haien etorkizuneko diru sarreretan (Porter eta Serra, 2020).
Ohikoa da azken urteetako unibertsitarioei lan alderdiei buruzko informazioa interakzio informalen bidez ematea. Jasotzen den informazioa eskatzen duenaren generoaren araberakoa bada, falta den informazioaren izaera ezagutu gabe, jasotakoa zehaztugabea den edo azpimarratua den planteatu gabe, zaila izango da desparekotasunak zuzentzea. Hala ere, emakumeak datuak eskatu aurretik alborapen horren kontziente badira, erne egongo dira, eta estereotipoa saihesteko ahalegina egingo dute, benetan haien etorkizuneko lanbide karreretan eragina izango duten galderak eginez.
Kontu batek agerian uzten du nolako eragina duen jasotako informazioak gizonek eta emakumeek hartzen dituzten arriskuetan: genero arrakalaren tamaina kontsumoko, finantzako eta lan merkatuko aukeren jakitun egoteko behar diren parametro ekonomikoen ezagutzan. Egia da genero desberdintasunak daudela ekonomiarekin zerikusia duten erabakiak hartzeko orduan, baina desberdintasun horiek murriztu egiten dira, pertsonek, inbertitzaileek eta etorkizuneko langileek (bai gizonek bai emakumeek) finantza ezagutzak badituzte (Dwyer et al., 2002). Horrek iradokitzen du informazio desberdintasunak izan daitezkeela arriskuak –behintzat finantzarioak– hartzeko jokabideen kausetako bat. Hau da, alderdi ekonomikoei buruzko zenbat eta informazio gehiago jaso, orduan eta handiagoa da eremu hori hautatzeko probabilitatea. Etorkizuneko enplegua aukeratzeko erabaki egokienak ahalik eta informazio gehien izanik hartzen direnak dira.
Hala, informaziorako sarbide desberdina izatea beti da lan hautuetan desberdintasunak agertzeko baldintzatzaile bat, eta, ondorioz, horrek diru sarrera handiagoak ala txikiagoak edo hazteko eta mailaz igotzeko aukera gehiago ala gutxiago dakartza. Garatzaile, ingeniari, matematikari, adimen artifizialeko edo datuen zientziatako lanetan diharduen emakume gutxien inguruan hausnartu, eta arlo horietako profesionalek azken urteetako emakumezko unibertsitarioengan duten inpaktu handia kontuan hartzen badugu, komeni da espezialista horiek ematen dieten informazioan estereotipoak baztertzea. Enpresek eta erakundeek haien kontratazio-politikak hobetu, eta enplegu baterako hautagaien generoan oinarritzen diren aurreiritziak alde batera uzten badituzte, lehen urratsa emango dute, emakumezko gazte askoren potentziala mugatuta ez egoteko tradizioz gizonen mende egon diren eremuetan, eremuok faktore erakargarri asko izaten dituzte eta.
Erreferentzia bibliografikoak:- Dwyer, P.D., Gilkeson, J.H., List, J.A. (2002) Gender differences in revealed risk taking: Evidence from mutual fund investors. Economics Letters, 76 (2), 151–158. DOI: https://doi.org/10.1016/S0165-1765(02)00045-9
- Gallen, Y., Wasserman, M. (2021). Informed Choices: Gender Gaps in Career Advice. University of Chicago, Becker Friedman Institute for Economics Working Paper, 2021-23. Available at SSRN: https://ssrn.com/abstract=3786998 or http://dx.doi.org/10.2139/ssrn.3786998
- Porter, C., Serra, D. (2020). Gender Differences in the Choice of Major: The Importance of Female Role Models. American Economic Journal: Applied Economics 12 (3), 226–254. DOI: 10.1257/app.20180426
Marta Bueno Saz (@MartaBueno86G) Salamancako Unibertsitatean lizentziatu zen Fisikan eta Pedagogian graduatu. Gaur egun, neurozientzien arloan ari da ikertzen.
Jatorrizko artikulua Mujeres con Ciencia blogean argitaratu zen 2021eko ekainaren 8an: “Consejos gratuitos a las universitarias“.
Itzulpena: UPV/EHUko Euskara Zerbitzua.
The post Alferreko aholkuak emakumezko unibertsitarioei appeared first on Zientzia Kaiera.
Desmitificando: Corte de digestión
Aún es verano y época de baños. Aparece en los medios año tras año, aunque no exista ninguna evidencia médica o biológica que apoye el corte de digestión. Lo desmiente rotundamente Esther Samper en 2011: “El corte de digestión no existe como tal”. El extendido consejo de esperar dos horas entre la comida y el baño tampoco tiene una evidencia médica conocida.
Sin embargo, hay que tener precaución al iniciar el baño pues se puede provocar la hidrocución. Es el síncope provocado por el cambio brusco de temperatura al entrar con rapidez en el agua. Y, como es natural, es frecuente en verano y en época de baños, con una temperatura ambiente alta y baño en agua más fría.

Fue G. Lartigue, teniente coronel médico del ejército francés, el que propuso, en 1953, el término hidrocución, como análogo a electrocución, para describir la muerte por agua o por electricidad. Escribió que la hidrocución es “el golpe brutal del agua fría sobre el cuerpo humano”.
La hidrocución aparece por la diferencia de temperatura entre el agua y el organismo. Cuanto más fría esté el agua y más elevada sea la temperatura del cuerpo, mayor será el llamado reflejo de inmersión y la gravedad de la hidrocución. El contacto brusco en la piel y en el sistema respiratorio de agua a menos temperatura consigue que, en un acto reflejo, se inhiban la respiración y la circulación. Se puede provocar una pérdida de conocimiento que puede llegar, incluso, a una parada cardiorrespiratoria por arritmia cardíaca súbita.
Al entrar en agua fría, la primera respuesta es el reflejo de inmersión. La entrada de la cabeza en agua fría provoca la caída de la frecuencia cardíaca y se contraen los vasos sanguíneos superficiales para llevar más sangre al cerebro. Si la respuesta es fuerte, puede causar la muerte súbita. Cuanto más fría esté el agua y la temperatura del cuerpo sea más alta, mayor será la respuesta del reflejo de inmersión. En 2017 y en El País, Juan Revenga recomendaba no zambullirse bruscamente a menos de 18ºC, sobre todo si se ha estado al sol o haciendo ejercicio físico fuerte provocando la subida de la temperatura corporal.
No es fácil diagnosticar con seguridad la muerte por hidrocución en relación con la muerte por ahogamiento. Así concluyen su revisión de autopsias los forenses Michel Piette y Els de Letter, de la Universidad de Gante, en Bélgica. La muerte por hidrocución puede terminar con ahogamiento, con agua en los pulmones, o por parada cardiorrespiratoria súbita, sin entrada de agua. No hay agua en los pulmones y son los ahogados blancos o atípicos.
No hay registros que aclaren cuántos muertos por ahogamiento tienen por causa la hidrocución. Según Gracia Pablos, en El Mundo, los Institutos de Medicina Legal de Andalucía plantean que entre el 10% y el 40% de los ahogados podrían deberse a la hidrocución. Y precisan que el porcentaje más probable se acercaría al 40%.
El proceso de hidrocución, al contrario de lo que dice la creencia popular, no tiene relación con la digestión. Para Esther Samper es “la pérdida súbita de conocimiento o la muerte al sumergirse en el agua”, y no es necesario que el agua entre en los pulmones. En sentido estricto no es una ahogamiento.
Para evitar la hidrocución hay que entrar en el agua poco a poco, mojando cuerpo y cabeza progresivamente, comenzando por las muñecas, la nuca y la cabeza. Así, el organismo se va adaptando al cambio de temperatura.
Sin embargo, gran parte de la población sigue aceptando la existencia del corte de digestión y que es necesario aplicar las dos o tres horas de espera antes del baño. Borja Cendrero y Germán Ruiz, de la Universidad Complutense, encuestaron a 65 alumnos de 4º de la ESO, con 38 chicas, de 15 a 17 años, sobre esta cuestión. Más de la mitad, cerca del 53% creían que “bañarse en la piscina después de comer puede provocar un corte de digestión”.
Y siguen apareciendo citas al corte de digestión en libros de texto de primaria y secundaria. Inés Barrio y sus colegas, del Hospital de Baza, analizan 844 mensajes publicados en los textos. El 24.6% del total no se basa en ninguna evidencia científica y, entre esos mensajes, está el que indica “no nadar después de comer pues el proceso digestivo puede verse afectado”.
En conclusión y como resumen, el término “corte de digestión” no corresponde a ninguna entidad clínica reconocida y se refiere al síndrome de hidrocución. Como escribe Milagros Oyarzabal, de la Unidad Docente Multiprofesional de Atención Familiar y Comunitaria de Alicante, la hidrocución es un shock provocado por diferencia de temperaturas. Se puede presentar con temperaturas del agua inferiores a 27ºC o cuando la diferencia entre la temperatura del agua y del cuerpo es, al menos, de 5ºC.
Por tanto, no es la digestión sino la diferencia de temperatura entre el exterior y el cuerpo la causa de la hidrocución, como resume Alexandre López-Borrull desde la Universitat Oberta de Catalunya. De hecho, aunque en casos extremos hay vómitos durante la hidrocución, la digestión no se corta y continúa pues no es un proceso que se detenga o, si se quiere, que se corte.
Referencias:
Barrio-Cantalejo, I. et al. 2011. Are the health messages in schoolbooks based on scientific evidence? BMC Public Health 11: 54.
Cendrero-Rodríguez, B. & G. Ruiz-Tendero. 2020. Proyecto edusin (educa-salud: investiga y muévete seguro): un programa de intervención sobre los mitos en actividad física y salud. SPORT TK: Revista Euroamericana de Ciencias del Deporte 9: 23-31.
López-Borrull, A. 2021. Bulos científicos. De la tierra plana al coronavirus. Ed. Oberon. Madrid. 189 pp.
Oyarzabal Arocena, M. 2015. Corte de digestión. Actualización en Medicina de Familia 11: 358-360.
Pablos, G. 2018. ¿Por qué todavía hablamos de corte de digestión si en realidad no existe? El Mundo 2 septiembre.
Pietter, M.H.A. & E.A. De Letter. 2006. Drowning: Still a difficult autopsy diagnosis. Forensic Science International 163: 1-9.
Revenga, J. 2017. La verdad sobre el corte de digestión y otros mitos veraniegos. El País 7 agosto.
Samper, E. 2011. El corte de digestión: A fondo. El País 1 agosto.
Wikipedia. 2021. Hidrocución. 5 agosto.
Sobre el autor: Eduardo Angulo es doctor en biología, profesor de biología celular de la UPV/EHU retirado y divulgador científico. Ha publicado varios libros y es autor de La biología estupenda.
El artículo Desmitificando: Corte de digestión se ha escrito en Cuaderno de Cultura Científica.
Entradas relacionadas:- Desmitificando: La vitamina C y el resfriado
- Desmitificando: Las rubias son “tontas”
- Desmitificando: Adopción y embarazo
Argiak zuzendutako tratamendu alternatiboa minbiziaren kontra
Ikerkuntza zientifikoaren aztergaiak gizartearen kezkekin eta eskaerekin batera doaz. Osasun esparruan, gaixotasunak sendatzeko metodo terapeutiko berriak eta eraginkorragoak bilatzea erronka erakargarria eta beharrezkoa da. Minbiziak ardura nabarmena sortzen du biztanlerian, izan ere heriotza kausa ohargarrienetarikoa da mundu osoan. Gainera, minbizia tratatzeko erabiltzen diren metodo terapeutiko ohikoenak, kimioterapia eta erradioterapia, ez dira selektiboak eta albo-efektu kaltegarriak dauzkate gizakien osasunean. Ondorioz, ahalegin ugari egiten ari dira minbiziaren kontra egiteko metodo eraginkor eta selektiboagoak aurkitzeko. Ildo honetatik terapia fotodinamikoa (TFD) agertu da etorkizun handiko alternatiba bezala. Tratamendu honetan gizakiontzako toxikoak ez diren fotosentikortzaile izeneko molekulak erabiltzen dira. Molekula hauek minbiziaren ingurunean kokatzen dira eta bere efektu terapeutikoa argiaren bidez kontrolatzen da. Izan ere, irradiazioaren ondorioz fotosentikortzaileek oxigeno singletea ekoizten dute inguruneko oxigenotik. Espezie gako hau oso erreaktiboa da eta bere ingurunean dauden zelula kantzerigenoak suntsitzen ditu. Irradiazioa gelditzen denean aktibitate zitotoxikoa desagertzen da eta fotosentikortzailea guztiz geldoa da, inongo eraginik gabe inguruko zelula osasuntsuetan.

Argiak zuzendutako terapia berritzaile hau eraginkorra izateko fotosentikortzaileen diseinu aproposa ezinbestekoa da. Alde batetik, argia xurgatzeko ahalmen altua eduki behar dute, batez ere gorriko (650 nm-tik gora) edo infragorri hurbileko (750 nm-tik gora) eremu espektraletan, eta luzaro iraun etengabeko irradiazio jasateko. Modu honetan bermatzen da argia sakonki sartzea ehunetan (3 eta 5 mm inguru) eta eraginkortasunez iristea minbizira, inguru biologikoarekin interferentziak murriztuz. Beste alde batetik, sistemen arteko gurutzaketaren probabilitate handia eduki behar du. Egoera kitzikatuan eta irradiazioaren ondorioz gertatzen den prozesu fotofisiko hau ezin bestekoa da oxigeno singletea sortzeko.
Betebehar hauek guztiak lortzeko molekula organikoak aproposak dira, haien biobateragarritasunagatik eta molekula-egitura borondatez eraldatzeko erraztasunagatik. Hori dela eta, azken urteotan BODIPY izeneko (BOron DIPYrromethene) koloratzaileek jarrera bikaina erakutsi dute fotosentikortzaile bezala minbizia tratatzeko TFD-ren bidez. Kromoforo hau kimikoki oso egonkorra da eta moldakortasun kimiko handia erakusten du. Beraz, bere oinarrizko egitura erraz eraldatu daiteke eta propietate fotofisikoak modulatu borondatez. Adibidez, haien xurgapen gunea ikusgaiko alde gorrira eramateko talde aromatikoak eransten dira eta sistemen arteko gurutzaketa bultzatzeko eta, bide batez, oxigeno singletearen sorrera ahalbidetzeko, estrategia desberdinak daude. Hala nola, atomo astunak eranstea, karga-transferentzia prozesuak sortaraztea, edota biak konbinatzea. Ondorioz BODIPYan oinarritutako fotosentikortzaileak garatu dira non oxigeno singletearen sorrera lortu den %95-eko etekinarekin 650-800 nm uhin luzeradun kitzikapenaren ondorioz.
Hala eta guztiz ere aurrerapauso gehiago behar dira terapia fotodinamikoa minbizia sendatzeko alternatiba erreal bezala guztiz inplementatzeko. Momentuz, batez ere erabiltzen da tratamendu osagarri bezala larruazaleko gaixotasunetarako. Izan ere, argiaren barneratzea ehunetan 1 cm-ko sakontasunekoa da kasu onenetan, nahikoa epidermisa eta dermisa zeharkatzeko, baina argia sakonagoko organoetara bideratzea ez da erraza. Hurrengo erronka oxigeno singletearen sorrera kontrolpean modulatzea da molekula-egituraren bidez. Hau da, fotosentikortzaileak ahalmen fluoreszentea neurri batean mantentzea, oxigeno singletea sortzeko gai den bitartean. Modu honetan, molekula berbera erabil daiteke minbizia tratatzeko, oxigeno singletearen bidez, eta baita honen kokapena detektatzeko, bere igorpen fluoreszentea jarraituz. Hau da, molekula bera erabiliz diagnosia eta terapia egitea, teragnosia bezala ezagutzen dena. Honetarako, fotosentikortzaileak zelula kantzerigenoetara selektiboki bideratzea oso interesgarria da hauen sentikortasuna bultzatzeko, zeren eta argiztatutako gunean bakarrik sortuko baita oxigeno singletea, kaltetutako zelulen inguruan. Berriro, BODIPY plataforma molekular ideala da baldintza hauek guztiak batera betetzeko molekula bakar batean.
Iturria:
Sola, Rebeca; García Martínez de la Hidalga, Enrique; Bañuelos, Jorge (2020). «Argiak zuzendutako tratamendu alternatiboa minbiziaren kontra»; Ekaia, 37, 2020, 145-157. (https://doi.org/10.1387/ekaia.20722)Artikuluaren fitxa:
- Aldizkaria: Ekaia
- Zenbakia: Ekaia 37
- Artikuluaren izena: Argiak zuzendutako tratamendu alternatiboa minbiziaren kontra.
- Laburpena: Osasunaren esparruan, minbizia da gaixotasunen artean gizartearen kezka garrantzitsuenetarikoa beraren heriotza-tasa altua dela eta. Ikerkuntzan ahalegin nabariak eta ugariak egiten ari dira minbizia sendatzeko, metodo terapeutiko berriak bilatzeko, eta erradioterapiaren eta kimioterapiaren albo-efektu kaltegarriak ekiditeko. Azken bolada honetan, alternatiba osagarri gisa terapia fotodinamikoak arrakasta izan du, batez ere larruazaleko minbiziak tratatzeko. Metodo honetan argiak fotosentikortzaile bat aktibatzen du oxigeno singletea sortzeko. Izan ere, azken espezie hori zitotoxikoa da, eta aktibitate antikantzerigenoa erakusten du. Lan honetan, arreta fotosentikortzaileetan jartzen da. Zehazki, horien zenbait alderdi garrantzitsu azaldu eta aztertzen dira, hala nola haien diseinu molekularra, bete behar dituzten eskakizunak aipatuz, eta orobat azalduz zer prozesu fotofisiko dauden argiak zuzendutako oxigeno singletearen sorreraren atzean. Bukatzeko, adierazten dira gaur egun eskuragarri dauden fotosentikortzaile organikoak, bereziki BODIPY izeneko koloratzaileak azpimarratuz.
- Egileak: Rebeca Sola, Enrique García Martínez de la Hidalga, Jorge Bañuelos
- Argitaletxea: UPV/EHUko argitalpen zerbitzua
- ISSN: 0214-9001
- eISSN: 2444-3255
- Orrialdeak: 145-157
- DOI: 10.1387/ekaia.20722
————————————————–
Egileez:
Rebeca Sola, Enrique García Martínez de la Hidalga eta Jorge Bañuelos UPV/EHUko Zientzia eta teknologia Fakultateko Kimika Fisikoa Sailekoak dira.
———————————————–
Ekaia aldizkariarekin lankidetzan egindako atala.
The post Argiak zuzendutako tratamendu alternatiboa minbiziaren kontra appeared first on Zientzia Kaiera.
Dozena erdi ariketa 2021eko udarako: erantzunak
Kantitate bat ordaindu ahal bada, horri 5en multiploak gehituta lortzen diren guztiak ere ordaindu ahal dira. Horretan oinarrituta, 5ekiko zatiketek uzten duten hondarraren arabera antolatuko ditugu zenbakiak.
5 10 15 20 25 30 35 1 6 11 16 21 26 31 36 2 7 12 17 22 27 32 37 3 8 13 18 23 28 33 38 4 9 14 19 24 29 34 39Lerro bakoitzean gorriz daudenak ezin dira lortu 5eko eta 7ko txanponak erabiliz. Lehen lerroko guztiak 5eko txanponekin lortzen dira. Beste lerroetan, lehen zenbaki beltza 7ko txanponekin lortzen da eta besteak 5ekoak gehituta. Ordaindu ezin den kantitate handiena 23 da, beraz.
Joseluren eta Koldoren erantzunak zuzenak dira. Joselurena ederto azalduta, gainera.
ABC triangelua zuzena denez, Pitagorasen teorematik AC = 5 cm ateratzen dugu. Orduan, ACD triangelua isoszelea da eta CM altuerak bi triangelu zuzen berdinetan zatitzen du. AM = MD = 3 cm denez, hiru triangelu zuzen berdin ditugu. Bakoitzaren azalera (3 x 4) : 2 = 6 cm2 da. Hortaz, laukiaren azalera 18 cm2 izango da.
Iñakik, Estik, Koldok eta Joseluk zuzen eman dute 18 balioa. Batzuek 18 cm idatzi dute, 18 cm2 beharko zuen lekuan.
3. Zenbat triangelu egin daitezke hiru erpinak kolore bereko puntuetan hartuta?
Kolore bakoitzeko puntuekin zenbat hirukote egin daitezkeen kalkulatu behar dugu eta hirukotearen puntuak lerro zuzen berean suertatzen diren kasuak kendu.
Sei puntu gorriek (6 x 5 x 4) : (3 x 2) = 20 hirukote ematen dituzte, eta hamar puntu urdinek, (10 x 9 x 8) : (3 x 2) = 120 hirukote. (Konbinazioetarako formula erabili dugu.) Denetara, 140 hirukote ditugu.
Irudian ikus daitekeenez, bi hirukote gorrik dituzte puntuak lerrokatuta. Urdinen kasuan, alde batetik bost hirukote kendu behar dira (irudiko 3tik 7ra), eta beste alde batetik azken zutabeko lau puntuek kendu beharreko lau hirukote ematen dituzte. Denetara, 11 hirukote kendu behar dira.
Hortaz, 140 – 11 = 129 triangelu egin ditzakegu erpinak kolore bereko puntuetan hartuta.
Joseluk zuzen eman du erantzuna.
Hasierako abc zenbakiak 100 a + 10 b + c adierazten du; amaierako cba, 100 c + 10 b + a izango da. Kenketa eginez, 99 c – 99 a = 99 (c – a) km egin ditu Jonek. Ibili den ordu kopurua t bada, 99 (c – a) = 55 t edo 9 (c – a) = 5 t dugu. Hortik, c – a = 5 ateratzen dugu. Izan ere, c – a 5en multiploa izan behar da eta 0tik 9rainoko zifrak izanik, c – a = 0 edo 5 bakarrik gerta daitezke. Ezarritako baldintzak kontuan hartuta, c = 6, a = 1 eta b = 0 lortzen dira. Hasieran kontagailuak 106 markatzen zuen.
Koldok, Joseluk eta Iñakik zuzen erantzun dute.
Egin dezagun OAB triangelua irudiak erakusten duen moduan.
OA = 2 cm (zirkuluaren erradioa) eta OM = √3 cm (karratuaren aldearen erdia) dira. Pitagorasen teorema erabiliz, AM = 1 cm dugu. Beraz, AB = 2 cm da eta OAB triangelua aldeberdina da. Orduan, triangeluaren angeluak 60 o dituzte eta AB arkua zirkunferentzia osoaren seirena da. Zirkunferentziaren luzera 4π denez, 4π/6 = 2π/3 cm da arkuarena. Karratuaren alde bakoitzari 2 cm kendu dizkiogu (AB-ren luzera). Dena kontuan hartuta, irudiaren perimetroa hau da:
4 (2π/3 + 2√3 – 2) = 8 (π/3 +√3 – 1) = 14.23398687…
Mendibero eta Iñakiren erantzunak zuzenak dira.
Bilatzen ari garen zenbakiari 1 gehituta hondar guztiak 0 bilakatuko dira, hau da, 2, 3, 4, 5, 6, 7, 8 eta 9 zenbakien multiploa izango dugu. Hortaz, zenbaki horien guztien multiplo komun txikiena aurkituko dugu. Nahikoa da 5, 7, 8 eta 9ren multiploa izatea, horrek ziurtatzen baitigu 2, 3, 4 eta 6ren multiploa izatea. 5, 7, 8 eta 9ren multiplorik txikiena 5 x 7 x 8 x 9 = 2520 da. Beraz, ariketak eskatzen duen zenbakia 2519 da.
Mendibero eta Iñakiren erantzunak zuzenak dira.
——————————————-
Egileaz: Javier Duoandikoetxea Analisi Matematikoko Katedradun erretiratua da UPV/EHUn.
——————————————-
The post Dozena erdi ariketa 2021eko udarako: erantzunak appeared first on Zientzia Kaiera.
¿No es la vida misma una paradoja?
Uno se fabrica a sí mismo, uno forja la materia que se le da al azar.
Pensamientos de Martha (en [1]).

L’homme du Hazard (El hombre del azar, también traducido como El hombre inesperado en alguna de sus representaciones) es una obra de teatro de Yasmina Reza (1959), estrenada en septiembre de 1995 en París.
El concepto de azar acompaña los monólogos de los dos personajes: un famoso escritor y una de sus lectoras. Pensemos en las siguientes cuestiones: ¿Qué probabilidad tiene un escritor de éxito de coincidir en el compartimento de un tren con una de sus lectoras? ¿Y qué probabilidad tiene una persona de encontrarse sentada frente a un escritor al que sigue de manera incondicional en el trayecto de un viaje en ferrocarril? Parecería que no son muchas. Sin embargo, en L’homme du Hazard, este improbable suceso tiene lugar.
Paul Parsky es un famoso y amargado escritor que viaja de París a Frankfort en tren. Frente a él se sienta Martha, una de sus admiradoras. Lleva precisamente en su bolso el último libro del autor: El hombre del azar.
Cada uno de ellos va sumido en sus pensamientos. Él, en tono quejoso, repasa mentalmente su vida y su obra. Ella acaba de perder a un amigo muy querido y se siente desamparada. Martha reconoce al escritor; desearía hablar con él, pero no se atreve a sacar el libro de su bolso. Teme una mala reacción de Parsky, que acabaría rompiendo la fascinación que le produce.
Pensando para sí misma, sin atreverse a hablar con él, Martha imagina lo que podría decir al escritor:
Señor Parsky, el azar de la vida, el maravilloso azar de la vida –no el azar a secas– el azar de la vida ha hecho que le encuentre en este tren, no puedo evitar decirle…
Él se fija en ella; tampoco sabe cómo entablar conversación.
El público de la obra se convierte en un voyeur privilegiado, que logra conocer a través de ellos sus fantasías, sus mezquindades y sus temores que les impiden acercarse al otro.
Martha decide finalmente sacar el libro de su bolso y comenzar a leer. Parsky imagina que ella debe estar leyendo una parte del libro en la que se revela que el protagonista tiene un trastorno obsesivo compulsivo –lo calcula, lo enumera todo–, porque observa que ella sonríe. En realidad, el hermano de Martha padece esta enfermedad –se refieren a ella como la enfermedad del contaje–, una obsesión que le impide, por ejemplo, pisar los azulejos de color negro del embaldosado de su casa.
Martha confiesa finalmente a Parsky que le ha reconocido y admite la emoción que ha sentido leyendo sus libros. Él ríe complacido: es precisamente la reacción que ella deseaba.
De Yasmina Reza pasamos a otro escritor, Lewis Carroll (1832-1898), para seguir hablando del azar. En [2], el autor propone el siguiente problema:
Un saco contiene dos fichas, de las que se sabe que pueden ser de color blanco o negro. ¿Puedes prever su color sin sacarlas de la bolsa?
El autor afirma que una de las fichas es negra y la otra blanca… y lo argumenta del siguiente modo.
Observación Previa: Si la bolsa contuviera dos fichas negras (n) y una blanca (b), la probabilidad de sacar una ficha negra es de 2/3, y es el único caso en el que la probabilidad da este valor.
En la bolsa del problema planteado tenemos dos fichas, así que:
1) la probabilidad de que contenga dos fichas blancas (suceso B) es de 1/4: un caso favorable (b,b) entre los cuatro posibles (b,b), (b,n), (n,b) y (n,n);
2) la probabilidad de que el saco contenga una ficha blanca y otra negra (suceso BN) es de 1/2: dos casos favorables (b,n) y (n,b) entre los cuatro posibles (b,b), (b,n), (n,b) y (n,n);
3) la probabilidad de que el saco contenga dos fichas negras (suceso N) es de 1/4: un caso favorable (n,n) entre los cuatro posibles (b,b), (b,n), (n,b) y (n,n).
Es claro que {B,BN,N} es un sistema completo de eventos.
Ahora introducimos una ficha negra en la bolsa y llamamos A al evento “se saca una ficha negra de la bolsa que contiene las tres fichas”.
Y Carroll sigue argumentando, utilizando como herramienta el teorema de la probabilidad total:
P(A) = P(A/B) x P(B) + P(A/BN) x P(BN) + P(A/N) x P(N) =
= 1/3 x 1/4 + 2/3 x 1/2 + 1 x 1/4 = 2/3.
Es decir, es la misma que la probabilidad de extraer una ficha negra cuando el saco contiene dos fichas negras y una blanca. Así, Carroll concluye que, antes de añadir la ficha negra, la bolsa contenía una ficha negra y una blanca. Tras dar esta solución “aparentemente seria” al problema, Lewis Carroll lo remata con esta irónica frase:
To the casual reader it may seem abnormal, and even paradoxical; but I would have such a reader ask himself, candidly, the question “Is not, Life itself a Paradox?”.
[Para el lector casual, puede parecer anormal e incluso paradójico; pero quisiera que un tal lector se hiciera a sí mismo, con franqueza, la pregunta «¿No es la vida misma una paradoja?».]
Sin duda lo es…
Referencias
[1] Yasmina Reza, L´homme du hasard, Actes Sud, 1995.
[2] Lewis Carroll, The Mathematical Recreations of Lewis Carroll: Pillow Problems and a Tangled Tale Reading, Dover, 2003.
Sobre la autora: Marta Macho Stadler es profesora de Topología en el Departamento de Matemáticas de la UPV/EHU, y colaboradora asidua en ZTFNews, el blog de la Facultad de Ciencia y Tecnología de esta universidad
El artículo ¿No es la vida misma una paradoja? se ha escrito en Cuaderno de Cultura Científica.
Entradas relacionadas:- La paradoja de Bertrand
- ¿Adivinando o empleando la lógica?
- Una paradoja del infinito: la oferta del diablo
Akatsek genetikaren ikerkuntza oztopatzen dutenean
Zientziaren oinarrietako bat da emaitzak errepikatu ahal izatea. Hau da, esperimentu bat baldintza berdinetan eta prozedura berdinarekin errepikatzen bada, emaitza berberak lortu beharko lirateke. Hori posible egiteko, ikertzaileek azaldu egin behar dituzte esperimentuaren xehetasun guztiak eta berri eman emaitzei buruz zehatz-mehatz. Hala, posible da beste ikertzaile batzuek esperimentu horiek errepika ditzaten eta emaitzak erka daitezen. Baina zer gertatzen da bidean akatsen bat egiten bada?
Genetikan bada oso xelebrea eta ezaguna den akats bat: geneen izenak nahi gabe aldatzea. Arazo horren jatorria dago Excel edo Google Sheets programa ospetsuen autozuzentzaileetan. Autozuzentzaileek uste dute SEPT4 edo MARCH1 geneak datak direla eta “irailak 4” edo “martxoak 1” izenpean gordetzen dituzte. Honek arazoak sortzen ditu zerrenda horien analisi gehigarriak egiteko orduan –analisi berri horietan ez baitira gene horien izenak kontutan hartuko–; edo zerrenda horiek berrerabiltzeko orduan. Hala, analisi berriak eta erkaketak ez dira izan beharko liratekeen bezain zorrotzak eta zuzenak izango.

Arazo honen berri eman zen lehenengo aldiz 2004. urtean. Arazoaren hedapena, berriz, 2016. urtean aztertu zuen lan batek. Lan horretan aztertu zituzten genomikako aldizkaririk garrantzitsuenetan informazio gehigarri gisa argitaratzen ziren kalkulu-orriak. Bada, kalkulu-orri horien %20k izan zuten akatsen bat geneen izenetan. Esan bezala, arazoa aspalditik ezaguna bada ere, oraindik buruhausteen iturri da. Lan berri batean aztertu dira 2014. eta 2020. urteen artean argitaratu diren 11.000 artikulurekin batera eskuragarri jarri diren kalkulu-orriak, eta horien heren batean akatsak aurkitu dira geneen izenetan.
Arazo hau hain hedatua dagoenez –eta arazo hau saihesteko saiakerek huts egin dutenez–, giza geneak izendatzen dituen erakundeak 27 generi aldatu die izena. Adibidez, SEPT4 genea orain SEPTIN4 izendatzen da eta MARCH1, berriz, MARCHF1. Gaineratu behar da erakunde horrek lehenetsi egiten duela geneen izenak egonkor mantentzea; baina erabaki hori hartu behar izan du arazo honen larritasunaz jabetuta. Hala ere, oraindik goiz da neurri horrek arazoa saihestu ote duen jakiteko. Arazoari aurre egiteko beste estrategia batzuk izan daitezke akats horiek egiten ez dituzten kalkulu-orriak erabiltzea –adibidez, LibreOffice– edo kalkulu-orriak erabiltzeari uztea. Baina ohiturak aldatzea zaila da.

Genetikaren alorrean argitaratutako artikuluetan aurki daitekeen beste arazo bat ez da hain xelebrea eta, agian, ez da nahi gabe egiten. Arazo hori da okertzea gene bat ikertzeko erabili den sekuentziari buruz berri ematean.
2015. urtean hasi zen Jennifer Byrne ikertzailea genetikako artikuluetan akatsak aurkitzen. Orduan akatsak zituzten bost zientzia-artikulu aztertu zituen. Bost lan horietan ohiko esperimentu bat egiten zen: DNA sekuentzia labur bat erabiltzen zen gene baten funtzioa minbizi-zeluletan oztopatzeko eta, horrela, bere eragina zein zen aztertu ahal izateko. Bada, artikulu horietan aipatzen ziren sekuentziek ez zuten gene horien funtzioa oztopatzen. Byrne-ren susmoa da artikulu horiek jatorri berdina izan zutela. Ordutik, bost artikulu horietatik lau okerrak zirela onartu dute aldizkariek edo egileek.
2017. urtean Byrne-ri batu zitzaion Cyrik Labbé ikertzailea eta garatu egin zuten arazo hori aztertzeko programa bat. Programa horrek aztertu egiten zuen artikuluetan aipatzen ziren sekuentziak gene horienak ote ziren eta arazoren bat aurkitzerakoan ikertzaileek eskuz aztertzen zuten artikulua. Orain, garatu zuten programa hori erabili dute aztertzeko Gene aldizkariaren 7.400 artikulu eta Oncology Reports aldizkariaren 3.800 artikulu. Gainera, Byrne-k eta bere taldeak akats horiek aztertu dituzte, gainera, minbiziaren genetikaren hiru arlotan: microRNA deitzen diren gene-osagaiak aztertzen duten lanetan, botika jakinen eragina aztertzen duten lanetan, eta minbizian parte hartzen duten 17 geneen funtzioa aztertzen duten lanetan, hain zuzen ere. Guztira mota horretako 600 artikulu inguru aztertu dituzte. Hala, guztira bost mota edo iturritako 11.000 artikulu inguru aztertu ostean, 700 artikulu inguruk ez zuen berririk eman sekuentzia zuzenari buruz. Akastun artikulu horiek 78 aldizkari zientifikotan argitaratu ziren eta 17.000 aipu inguru jaso dituzte. Hau da, arazo oso hedatua da eta, agian, oharkabean pasatzen ari dena.

Aipatutako akatsak nahi gabe eginda egon daitezke, baina Byrne-ren iritziz susmagarria da giza geneekin erlaziorik ez duten sekuentziak giza geneak aztertzeko erabili direla esatea. Akats horien eraginez, ikerkuntza horiek erabilgarriak ez izatea suerta daiteke; edo halako lanak errepikatzea denbora alferrik galtzea izatea; edo arlo horretako ikerkuntzan dagoen konfiantza galtzea. Aspaldidanik aipatzen da ikerkuntzan errepikatzeko gaitasunari dagokiola arazo handia dagoela. Argi dago akatsek –nahi gabe edo nahita eginda– arazo hori handitzen dutela.
Genetikaren ikerkuntzan jarduten dugunok gizakiak gara eta, ondorioz, akatsak egingo ditugu. Baina gure eskuetan dago akats horiek saihestuko dituzten lanabesak, prozedurak eta kontrolak izatea, jokoan baitago sortzen dugun jakintzaren zuzentasuna, sinesgarritasuna eta erabilgarritasuna.
Erreferentzia bibliografikoak:Else, Holly (2021). Errors in genetic sequences mar hundreds of studies. Nature. Doi: https://doi.org/10.1038/d41586-021-02136-y
Lewis, Dyani (2021). Autocorrect errors in Excel still creating genomics headache. Nature. DOI: https://doi.org/10.1038/d41586-021-02211-4
Egileaz:Koldo Garcia (@koldotxu) Biodonostia OIIko ikertzailea da. Biologian lizentziatua eta genetikan doktorea da eta Edonola gunean genetika eta genomika jorratzen ditu.
The post Akatsek genetikaren ikerkuntza oztopatzen dutenean appeared first on Zientzia Kaiera.
Montañas y mitos
Para los pueblos de la antigüedad las montañas eran lugares terribles, pavorosos y misteriosos, en parte debido a sus distancias imponentes, a las cumbres rodeadas de nubes o humo y a los ruidos atronadores que provenían de ellas, pero también porque las montañas eran las moradas de los dioses.

Es raro encontrar en la literatura antigua relatos de humanos subiendo montañas, y cuando aparecen describen casos de imperiosa necesidad. Sin embargo, las montañas fascinaron tanto a los humanos que no pudieron evitar buscar explicaciones a los fenómenos extraños asociados con ellas. Los primeros intentos de explicación fueron mitológicos y fantásticos, algunos de los cuales veremos a continuación. Pero con el tiempo, los pensadores antiguos comenzaron a hacer preguntas sofisticadas y a encontrar respuestas naturalistas, lo que veremos en la próxima entrega de La maldición de Prometeo.

Los relatos míticos con las montañas como coprotagonistas se encuentran en muchas culturas del mundo. Los antiguos hindúes sentían una especial fascinación por Meru, una montaña legendaria al norte de la cordillera del Himalaya. Los hindúes y budistas de todo el sur de Asia construyeron montañas artificiales a imitación de Meru. Igualmente, los antiguos mesopotámicos, egipcios e indígenas americanos construyeron montañas artificiales (zigurats y pirámides) en un intento simbólico de acercarse a lo divino.
Las sociedades antiguas de Oriente Próximo también colocaron montañas reales como parte central de sus relatos que se reflejan en algunas de las publicaciones más antiguas del mundo. La epopeya de Gilgamesh, compuesta a fines del tercer milenio a.e.c., describe las aventuras del héroe Gilgamesh, quien se introdujo en el ámbito de lo divino, las montañas, y tuvo la valentía de ascenderlas en busca de la gloria.
Las montañas se asociaron con algunos de los dioses más importantes del panteón mesopotámico. Enlil, la deidad principal, controlaba una gran montaña celestial que contenía la tierra y el aire. Un monstruo protegía Mashu, dos picos gemelos donde el sol descendía y ascendía, y dentro de los cuales reinaba una oscuridad infernal. Los bosques de cedros, custodiados por el semidión Humbaba, originalmente en las laderas de las montañas Zagros, eran sagrados para Ishtar, una diosa de la fertilidad cuyo culto implicaba la prostitución sagrada. Gilgamesh y su amigo Enkidu ascendieron estas montañas, donde experimentaron visiones trascendentales que indicaban eventos futuros.

Algunos hebreos también tuvieron experiencias extraordinarias en montañas. La más conocida aparece en Shemot (conocido en la cristiandad como Éxodo),segundo libro de la Torá, compuesto muy probablemente durante el segundo milenio a.e.c., donde se describe al profeta Moisés recibiendo de Dios (Yahvé) el Decálogo, los Diez Mandamientos, en el Monte Sinaí, un pico de 2,285 metros en la Península del Sinaí. El Sinaí era aterrador, rodeado de “[…] truenos y relámpagos y una densa nube sobre el monte y un poderoso resonar de trompeta […]” (Éxodo 19:16). Los truenos que resuenan desde la cima de una montaña cubierta de nubes oscuras atravesadas por frecuentes relámpagos pueden sonar como una trompeta de otro mundo para la mente predispuesta.
El paisaje de Grecia es ondulado, con montañas y valles, pero pocas llanuras. Esta península rocosa que se adentra en el mar Mediterráneo, entre los mares Jónico y Egeo, acogió al cazador y al pastor pero también al poeta. Las montañas de Grecia asombraron y por ello inspiraron a los griegos a la hora de intentar encontrar explicaciones de su sublimidad, lo que derivó en un uso creativo de la lengua. Algunas grandes montañas del entorno griego que alimentaron la imaginación griega durante siglos fueron Parnaso, Nisa, Cilene, Ida, Dindymon y Olimpo [*].

La montaña más famosa era el Olimpo, que, como la montaña más alta de Grecia con 2,918 metros, se adaptaba perfectamente a ser el hogar de los dioses. Los griegos se negaron a subir a la montaña debido a su altura, su dificultad y sus estatus sagrado. Las nubes a menudo ocultaban la cumbre distante, una cobertura perfecta para las secretas vidas eternas de los dioses. Las tormentas frecuentes no podían ser otra cosa que Zeus asintiendo con su gran cabeza atronadora y deidades como su hija Atenea lanzándose a la tierra, a la velocidad de un rayo, para difundir la voluntad del padre. Desde la perspectiva del Olimpo, los dioses observaban el comportamiento humano, escuchaban (o no) peticiones y súplicas y emitían juicios basados en su conciencia del futuro a la luz del presente y el pasado. La montaña simbólicamente se elevaba por encima de la ignorancia y el tiempo humanos, proporcionando los brillantes rayos de la verdad atemporal.
Los griegos estaban más familiarizados con el mar que con las montañas. Ambos ámbitos eran asombrosos y aterradores, pero las montañas lo eran tanto más porque estaban cerca, siempre a la vista, eran imponentes siempre y, en última instancia, desconocidas. Las montañas sirvieron para explicar fenómenos desconcertantes como los relámpagos y los truenos; las laderas misteriosamente boscosas; el temblor de la tierra; los frecuentes cambios del cielo y los fenómenos meteorológicos; el sentido sublime de lo divino encarnado en las partes inaccesibles de la naturaleza; y, en definitiva, eran el nexo entre tierra y cielo.
Nota:
[*] El mundo griego estaba rodeado por dos titanes que sufrían las consecuencias de la desobediencia a Zeus. Atlas en el oeste sostenía los cielos, sus hombros parecían enormes picos. En el este, en el extremo del mundo eran las montañas del Cáucaso, donde Prometeo estaba encadenado a una roca, soportando diariamente la tortura de un buitre que le mordía el hígado. Más cerca de casa, Parnaso, a más de 2.400 metros de altitud, se alzaba sobre Delfos, el Oráculo sagrado para el dios arquero Apolo; Parnaso fue también el hogar de las doce musas, las hijas de Zeus. El monte Nisa en Tracia estaba consagrado al dios del vino Dioniso. En Nisa, las ninfas de las montañas criaron al joven dios. El monte Cilene en Arcadia, el Peloponeso griego, fue el lugar de nacimiento de Hermes, el hijo alado de Zeus y Maya, la hija de Atlas. En el monte Cilene, Hermes inventó la lira a partir de un caparazón de tortuga. El monte Ida en Creta era sagrado para Zeus, el rey de los dioses y portador del rayo. Otro monte Ida (otra montaña del mismo nombre en el noroeste de Asia Menor) era famoso por albergar los ríos que regaron la Tróade, donde se encontraba la antigua Troya (Ilios). También en el monte Ida, Afrodita concibió al gran guerrero troyano Eneas. El monte Dindymom en Cícico era sagrado para una primigenia diosa de la fertilidad, Rea, madre de Zeus y esposa de Cronos.
Sobre el autor: César Tomé López es divulgador científico y editor de Mapping Ignorance
El artículo Montañas y mitos se ha escrito en Cuaderno de Cultura Científica.
Entradas relacionadas:Tokian tokiko jarduera: RNA eraldatutik sortutako hezurrak eta 3D inprimagailuak
Herrialde garatuetan biztanleria zahartuz doa. Ekonomia, osasun eta gizarte aurrerapenak direla eta, emakumeek ez dituzte hainbeste seme-alaba izaten eta, beraz, horretan ere zahartuz doaz, adinaren batezbestekoari begiratuta askoz ere gazteagoak badira ere. Gauza jakina da zahartze orokortua makrojoera demografiko eta, horrenbestez, ekonomiko handienetako bat dela aurreikus daitekeen etorkizunean.
Zahartzearekin batera, aldaketak gertatzen dira kontsumoan –zer eta nola kontsumitzen den– eta gaixotasun ohikoena zein izango diren ere esan daiteke, adinekoek izan ohi dituztenak direlako. Adibidez, minbizia eta gaixotasun neurodegeneratiboak geroz eta ohikoagoak izango dira, eta horrek estatistikoki ilundu egiten ditu gaixotasun horien aurka egiteko egiten diren aurrerapenak. Horregatik da hain garrantzitsua prebentzioan, oinarrizko zientziaren garapenean eta ondorengo terapietan inbertitzea, hala, tratamenduek aurrea har dezaten.
Zahartzeari lotuta dauden eta hain deigarriak ez diren beste patologia batzuk hezurren endekapenarekin lotuta daude, besteak beste, osteoporosia. Kalkuluen araber, mundu osoan 50 urte baino gehiagoko hiru emakumetik batek eta bost gizonetik batek hezur haustura osteoporotiko bat izango du. Gainera, haustura gehienak tratamendu egokiarekin arazorik gabe osatuko badira ere, beste kasu batzuetan hezurren birsorkuntzan kaltea gertatzen da; adibidez, auto istripuetan traumatismo handiak gertatzen direnean gero izaten diren infekzioetan.

Odolaren ondoren, hezurrak dira gehien transplantatzen den ehuna eta, beraz, transplanteak egiteko hezurren eskaria gehitu egingo da etorkizunean. Horregatik, hezurra birsortzen edo berregiten saiatzeaz gain, beharrezkoa da hezur ehunari lotutako behar berriak tratatzea.
AO Research Institute Davosek (Suitza) gidatutako cmRNAbone proiektuaren xedea da terapia geniko berri bat garatzea, zauri traumatiko handiak edo hezurretako gaixotasun degeneratiboak –besteak beste, osteoporosia– dituztenen bizi kalitatea hobetzeko.
Proposatu duten ikuspegian, ikerketa genetikoa, nanoteknologia eta bioteknologia aurreratua eta 3D inprimaketa uztartzen dira: RNAko agente terapeutikoekin lotutako aurkikuntza zientifiko berriak erabiliz, partzuergo horren xedea da kimikoki eraldatutako RNA garatzea (cmRNA, ingelesez) eta, horren ondoren, neurogenesi, baskulogenesi eta osteogenesirako proteina espezifikoak kodifikatzea, hiru prozesu horiek ezinbestekoak baitira osatze prozesuan aurrera egiteko. Sortutako RNA multzoak biralak ez diren emate bitartekoekin (bektoreak) konbinatuko dira, biomaterialeko tintaren formulazio batean eransteko RNA hornidura. Bereziki inplanteetarako diseinatutako 3D inprimagailua erabilita, errazagoa izango da praktikan frogatzea hezurrak birsortzeko dituen gaitasunak.
Aurkikuntza berriak aldi bereko bi azterketa aurreklinikotan aplikatuko dira, hezurretako akats osteoporotikoetan eta larrietan diseinatutako terapiaren baliozkotasuna eta garrantzia klinikoa frogatzeko. Aholku batzorde kliniko eta zientifiko baten babesarekin, zenbait enpresa txiki eta ertainek zuzendutako partzuergo horrek ziurtatuko du proiektua bukatzean erraz eta azkar itzuliko dela klinikaren eremura. Epe luzera, aurkikuntzek, gazteen eta adinekoen haustura txikietarako eta hezurretako kalte handietarako ikuspegi birsortzailea izateaz gain, milioika pazientek dituzten beste gaixotasun handietarako ere ikuspegi bera izan dezakete.
Hain zuzen, CIDETEC Nanomedicine euskal enpresak garatuko ditu polisakaridoetan oinarrituta egongo diren cmRNA bektoreak, ez-biralak, garatutako matrizera egokituak, hala, hezurra birsortzeko.
Egileaz:Cesár Tomé López (@EDocet) zientzia dibulgatzailea da eta Mapping Ignorance eta Cuaderno de Cultura Cientifica blogen editorea.
Itzulpena: UPV/EHUko Euskara Zerbitzua.
The post Tokian tokiko jarduera: RNA eraldatutik sortutako hezurrak eta 3D inprimagailuak appeared first on Zientzia Kaiera.